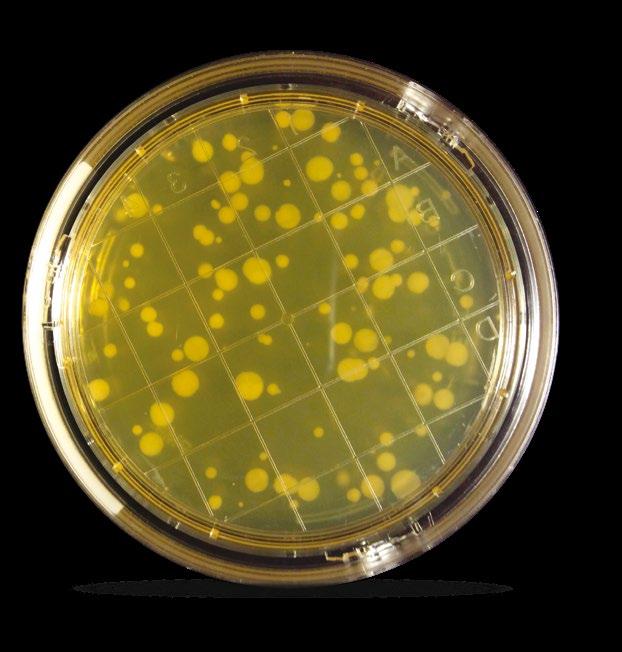
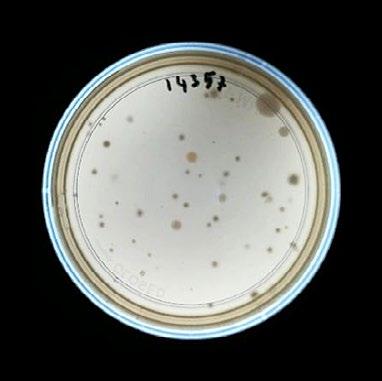
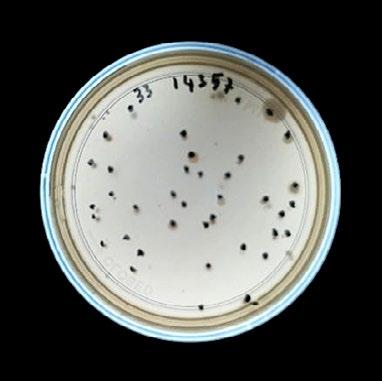
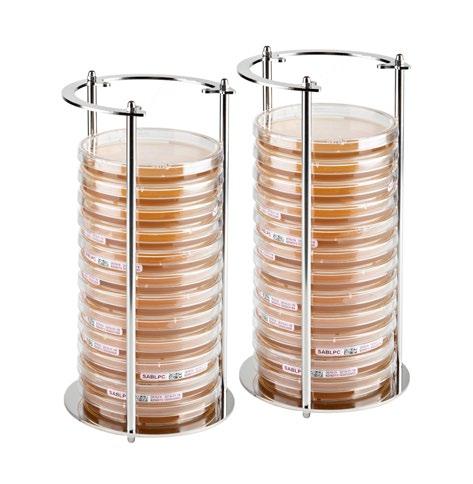
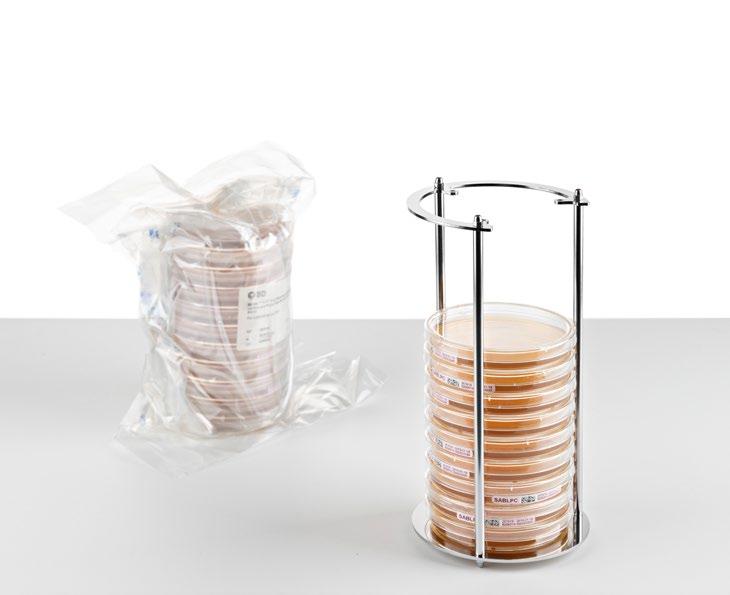
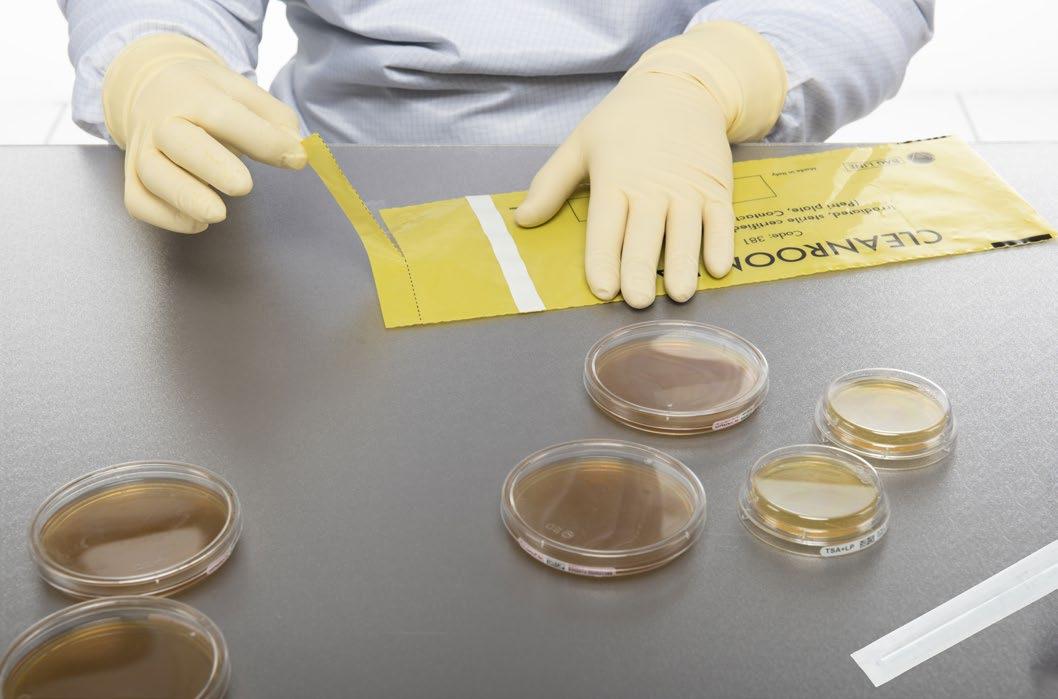

MICROBIAL ENVIRONMENTAL MONITORING 2024
A WIDE RANGE OF SOLUTIONS TO FIT YOUR BEST PRACTICE

CALIBRATION CERTIFICATE ISSUED WITH EACH INSTRUMENT

YELLOW FAMILY









STAINLESS STEEL FAMILY






CALIBRATION CERTIFICATE ISSUED WITH EACH INSTRUMENT













1 - WHICH IS THE TERMINOLOGY (GLOSSARY) INVOLVED IN MAM?
Active sampling, Air flow l/m, ALCOA, Bacteria, Colony forming unit (Cfu), Contact plate, Contamination, Culture Media, Culture plate, Data integrity, Disinfection, Fungi, Incubation, PQ, IQ, OQ Document, ISO, Yeast, Micron, Micro-organism, Moulds, Passive sampling, Petri dish, SDA agar media, Settle, Sterilization, TSA agar media, USP, Unviable particles, Viable particles
2 - WHY IS THE MICROBIAL CONTENT OF THE AIR TESTED?
The air contains micro-organisms that are “positioned” on the airborne dust. Such micro-organisms can contaminate sterile pharmaceutical products, reduce the shelf-file of food, dairy products, infect patients in hospital, contaminate by moulds HVAC of building, destroy old artistic pictures, contaminate theatres, offices, schools, trains, etc.
3 - WHAT’S THE DIFFERENCE BETWEEN A PARTICLE COUNTER AND A MICROBIAL AIR SAMPLER?
The particle counter takes a quickly measuring of unviable particles; the microbial air sampler takes a measuring of viable particles. Particle counter cannot distinguish viable and unviable particles and doesn’t provide information on the microbiological content of the environment. The particle counter is the answer for an immediate unviable particle result, the microbial air sampler is the answer for a microbial content after incubation. Both methods are therefore used for E.M.
4 - WHAT IS THE DEFINITION OF MAM (MICROBIOLOGICAL AIR MONITORING)?
Microbial Air Monitoring (also called Viable Air Monitoring) has the purpose to capture samples of micro-organisms (bacteria, moulds, yeast) suspended in the air on a nutrient media (inside a Petri dish) with subsequent incubation to highlight their growth after 2-3 days for bacteria and 3-6 days for moulds and yeasts.
5 - WHAT TYPE OF NUTRIENT AGAR IS USED FOR MAM?
Tryptic Soy Agar (TSA) is typically used for total bacterial count of bacteria; Sabouraud Dextrose Agar (SDA) is used for mould or yeast growth.
The minimum amount of agar in each Petri dish should be 12-15 ml for Contact plate and 25 -30 – 35 ml for standard Petri dish.
6 - WHAT IS THE INCUBATION TIME AND TEMPERATURE?
Bacterial samples are typically incubated for 48-72 hours at 30-37°C. Moulds and yeasts are typically incubated for 4-6 days at 26-30°C.
7 - WHAT IS THE DIFFERENCE BETWEEN ACTIVE MICROBIAL AIR SAMPLING AND PASSIVE (SETTLE) METHODS?
Active microbial air sampler aspirates a known volume of air that impacts at constant speed on the agar media surface collecting viable particles of different size in microns.
With Passive method (settle) the viable particles fall naturally onto the surface of an open Petri dish and their collection vary based on air flow, humidity, temperature and size of micro-organisms.
The active method reports quantitative results in the format of cfu / 1000 litres of air (=1 cubic meter); the settle method reports the results that fall on open agar surface in 4 hours.
The number of cfu collected by the active method is much larger that with settle method and the quantitative results can be applied to action and alert levels.
8 - WHICH IS THE FREQUENCY OF MICROBIAL AIR SAMPLING?
The frequency varies by industry and application.
The pharma companies that produce sterile products have to follow the indication of the Health Authorities and the CCS (Contamination Control System) specific for each producer. Indications can be found in the GMP Annex 1.
The frequency is daily for high-risk area and be-weekly or weekly for other sites.
The food, dairy, agro, poultry, beverage companies should make a preliminary investigation in their premises and production sites to find the best interval (daily, weekly, monthly?).
Dedicated Application Notes are available on request.
The frequency in hospital varies from high-risk sites (e.g.: type of operating room), high risk patient wards, etc, some indications are reported in the USP 1116 document Microbiological evaluation of Cleanrooms and other controlled environments. Compounding pharmacies are requested a calibration every 6 months.
In the case of building, the HVAC should be monitored inside and outside to compare the results as number of cfu. The inside number should never be higher that outside.
9 - HOW OFTEN AN ACTIVE MICROBIAL AIR SAMPLER SHOULD BE CALIBRATED?
The time is bounded to the frequency of use, but generally is every 6-12 months.
10 - SHOULD THE AIR FLOW RATE OF AN ACTIVE AIR SAMPLER CONTROL IN THE PERIOD BETWEEN THE OLD AND THE NEW CALIBRATION CHECK?
Yes. If the calibration is out of limit during the final check, all the results of the previous period are not accepted. A check at regular interval is therefore requested using the specific instrument.
11 - WHICH IS THE CORRECT VOLUME OF AIR TO BE ASPIRATED BY AN ACTIVE AIR SAMPLER?
The volume depends from the expected number of micro-organisms present in the environment under control. The number of cfu /plate should easy to count (not more than about 150 cfu) and therefore it is necessary to establish the volume to be aspirated (e.g.: 300 – 500 – 1000 litres). The obtained result should be then related to 1000 litres of air (1 cubic metre of air).
12 - SHOULD THE CFU OBTAINED FINAL RESULT OF AN ACTIVE AIR SAMPLER MODIFIED BY A STATISTICAL TABLE?
The instruction manual of each sampler reports a statistical table that should be applied to overcame the problem that more than a micro-organism is captured on the same hole of the agar surface.
13 - WHY ARE STERILE ASPIRATING HEAD FOR DAILY USE AVAILABLE?
The aspirating head of the air sampler is typically stainless steel made and must be autoclaved each day with related documentation. The availability of sterile techno-polymer heads (Daily Shift) that are used for a complete daily working shift avoids all the sterilisation iter and eliminated the possible false results.
14 - WHICH ACTIVE AIR SAMPLER SHOULD BE USED IN ISOLATOR AND RABS?
The command unit should be outside from the isolator to save inside space and reduce the risk of microbial contamination. The only part inside is the aspirating head or the funnel model.
15 - HOW ARE COMPRESSED AIR / GAS MONITORED FOR POSSIBLE CONTAMINATION IN GRADE A AND B?
The active air sampler connected to the TRIO.GAS instrument is used according to the guidelines outlined on the ISO 85737 document.
16 - IS A RE-VALIDATION NECESSARY FOR A NEW ACTIVE AIR SAMPLER-INSTRUMENT INTRODUCTION?
Yes. A New validation is necessary. A specific protocol is available.
17 - WHY TO USE AN ACTIVE AIR SAMPLER WITH AN ASPIRATION OF 200 LITRES PER MINUTE INSTEAD OF 100 LITRES PER MINUTE?
The sampling time of operator is reduced of 50% and a double number of tests are performed in comparison with 100 litres per minute.
18 - WHY IS SUGGESTED TO ADOPT AN ACTIVE AIR SAMPLER WITH 2 OR 3 ASPIRATING HEADS INSTEAD THAT JUST A SINGLE ONE?
There are several advantages:
• The use of different media at the same time (e.g.: TSA for bacteria and SDA for moulds)
• The use of the same media for real statistical results
• The use of the same media (e.g.: TSA) at different incubation temperature for bacteria and moulds
• To save operator time
• The application of continuous monitoring during the daily working shift
• To reduce the operator contamination risk because the plates handling is reduced
19 - IS IT POSSIBLE TO USE AN ACTIVE MICROBIAL AIR SAMPLER IN EXPLOSION RISK AREAS?
Yes. The model must be ATEX official certified.
20 - WHY ARE 55 MM CONTACT PLATES SOMETIMES ADOPTED INSTEAD OF THE TRADITIONAL 90 MM PETRI DISH FOR MICROBIAL AIR SAMPLING?
The reason is connected to the fact that some companies prefer to have just a single type of culture plate to reduce the validation of each separated lot.
21 - HOW ARE VIRUS CLLECTED FROM AIR?
The aerosol virus are collected in liquid for rapid analitical identification using the AIR.BIO ONE VIRUS AIR SAMPLER.

LESS THAN 2 MINUTES FOR 1000 LITRES OF AIR (3 HEADS)

SELFTEST

TO MONITOR THE DEVIATION OF THE FLOW RATE COMPARED TO THE CALIBRATION VALUE
VERITEST
TRIO.WIND
SYSTEM FOR OFFICIAL ANNUAL CALIBRATION

CFR21

BARCODE IDENTIFICATION 1D-2D FOR OPERATOR, LOCATION, PLATE

1°

2°
PASSWORD OPERATOR
PASSWORD MANAGER

EXPLOSION PROOF
INSTRUMENTS PRODUCED WITH COMPONENTS AND PROCESS ATEX CERTIFICATION
TECHNOPLASTIC SHOCKPROOF BODY WITH ANTIBACTERIAL TREATMENT

UP TO 70 CYCLES FOR 1000 LITRES/HEAD

CONTINUOUS SAMPLING
WATER & DUST PROTECTION IP 65
BLUETOOTH
TRANSFER
DATA

WIRELESS INDUCTIONS
BATTERY CHARGER
BASE STATION WITH BATTERY CHARGER
90/260V, AUTOMATIC VOLTAGE SELECTOR, CHECK CALIBRATION SYSTEM (OPTIONAL)
NO PLUG OR EXTERNAL CONNECTIONS
DISPOSABLE TRANSPARENT
TECHNOPOLYMER
CERTIFIED STERILE “DAILY SHIFT” HEAD
STAINLESS STEEL AISI 316 HEAD
CONTACT PLATE 55 MM
FAST CLOSING BAYONET
3 DIFFERENT BAYONET
STYLE ASPIRATING HEADS
REUSABLE TECHNOPOLYMER
AUTOCLAVABLE HEAD
PETRI PLATE 90 MM
SUITABLE FOR 55 MM CONTACT PLATE OR 90 MM PETRI PLATE
The Greek philosopher Aristotle (384–322 BC) was one of the earliest scholars who articulated the theory of spontaneous generation, the notion that life can arise from no living matter.

Italian Francesco Redi (1626–1697) and Lazzaro Spallanzani (1729-1799) performed experiments to refute the idea of spontaneous generation.



Luis Pasteur (1822-1895) set experiments that disproved irrefutably the theory of spontaneous generation.
Today the active air sampling confirms the Redi, Spallanzani and Pasteur conclusion theory.











(*) each PACK consists of: 1 air sampler with Bluetooth and battery charger, 1 calibration certificate, 2 s/s aspirating head (code 830) with s/s cover head (code 465), 1 cable for transfer data and 1 robustus carrying case.

(*) each PACK consists of: 1 air sampler with Bluetooth and battery charger, 1 calibration certificate, 1 s/s aspirating head (code 830) with s/s cover head (code 465), 1 cable for transfer data and 1 robustus carrying case.

(*) each PACK consists of: 1 air sampler with Bluetooth and battery charger, 1 calibration certificate, 3 s/s aspirating head (code 830) with s/s cover head (code 465), 1 cable for transfer data and 1 robustus carrying case.
Code RABS ISOLATOR for CONTINUOUS MONITORING
850K TRIO.BAS RABS ISOLATOR CM 25 l/m PETRI with 1 SATELLITE PACK (25 litres/min flow rate) (*)
(*) each PACK consists of: 1 TRIO.BAS RABS ISOLATOR with battery charger, 1 calibration certificate, 1 s/s satellite, 1 s/s aspirating head (code 830) with s/s cover head (code 465), 1 cable connection (5 mt) (code 265), 1 cable for data transfer and 1 robustus medium carrying case.
Code SATELLITE UNIT for CONTINUOUS MONITORING
851K CONTINUOUS SATELLITE UNIT Petri PACK
Code EACH PACK CONSIST OF:
830 S/S ASPI HEAD PETRI CM
465 COVER HEAD s/s to protect ASPI HEAD
265 Cable connection between the Satellite and the command unit - 1 set of 5 meters

+ 1

2



Code ACCESSORIES for REMOTE SYSTEM
140 s/s valve for REMOTE SYSTEM with 2 TRI clamps connection
184 silicone tube with 2 TRI clamps connection - 50 cm lenght
185 silicone tube with 2 TRI clamps connection - 100 cm lenght
186 silicone gasket for TRI clamp
187 s/s cap clamps
188 s/s 90° elbow short tube with 2 TRI clamps connection - wheelbase 40 mm
193 s/s tri clamps with silicone gasket
194 s/s tube with 2 TRI clamps connection - 100 mm lenght
Code REMOTE FUNNEL SYSTEM
181
REMOTE FUNNEL SYSTEM in s/s AISI316 with tri clamps connection, funnel and bell - carrying case included
Code REMOTE HEAD SYSTEM
192
REMOTE HEAD SYSTEM Petri 90 plate in s/s AISI316 with tri clamps connection - carrying case included
Code ACCESSORIES for REMOTE SYSTEM
194/1 s/s tube with 2 TRI clamps connection - 200 mm lenght
194/2 s/s tube with 2 TRI clamps connection - 500 mm lenght
195 s/s 90° elbow long tube with 2 TRI clamps connection - wheelbase 89 mm
197 s/s hexagonal pipe hook with inserts - 100 mm
189 s/s wall connection with 2 TRI clamps connection (wall < 5mm)
198 s/s wall connection with 2 TRI clamps connectionsize 80 mm lenght (wall > 5mm)
199 s/s floor pole - base diameter 250 mm - lenght 1 mt
1 - WHY IS IT NECESSARY IN GRADE “A” AND “B” OF CLEANROOM TO ADOPT A VIABLE CONTINUOUS MONITORING?
This is what is written in the GMP Annex 1 at the Chapter n.9.
9.24 Continuous viable air monitoring in grade A (e.g. air sampling or settle plates) should be undertaken for the full duration of critical processing, including equipment (aseptic set-up) assembly and critical processing. A similar approach should be considered for grade B cleanrooms based on the risk of impact on the aseptic processing. The monitoring should be performed in such a way that all interventions, transient events and any system deterioration would be captured and any risk caused by interventions of the monitoring operations is avoided.
2 - WHICH IS THE RISK OF CONTINUOUS PROLONGED MONITORING WITH “ACTIVE AIR SAMPLING”?
The culture agar medium is progressively dehydrated and it loses the nutrient characteristics for specific nutrients for different micro-organisms. The consequence is that the microorganisms can have difficult to multiplicate and the risk is the difficulty to have the correct colonies count.
3 - WHAT IS POSSIBLE TO DO FOR THE LIMITATION OF THE EXCESS DEHYDRATION OF THE CULTURE MEDIUM?
It is necessary to adopt an air sampler with a lower air flow rate (e.g.: 25 l/m) and to adopt Petri dishes with at least a volume of 30 ml of culture agar medium.
4 - WHY FOR CONTINUOUS MONITORING IS IT SUGGESTED TO ADOPT THE AIR SAMPLER WITH MORE THAN A SINGLE ASPIRATING HEAD?
Several are the reasons.
1.It is possible to divide the working shift time in different periods and in case of microbial contamination, it is possible to identify when the fact happened.
2.The operator handles the air sampler only at the beginning and at the end of activity and therefore the time is reduced with less possibility of contamination.
3.The adoption of the air sampler with satellites gives the possibility to monitor different risk positions.
5 - WHICH IS THE SUGGESTED ACTIVE AIR SAMPLER IN ISOLATOR?
The suggested air sampler is the “aspirating funnel” model because the housing of the culture plate is outside from the isolator and therefore the space is saved and the handling with the isolator gloves is eliminated an alternative is the “aspirating head” model.
6 - IS IT SUGGESTED TO ADOPT 2 OR 3 ASPIRATING HEADS?
It depends how long is the working shift. Up to four hours the 2 aspirating heads model is o.k. With longer time, the 3 aspirating heads are suggested.
7 - WHY TO USE “DAILY SHIFT” STERILE ASPIRATING HEADS?
The adoption of the sterile “Daily Shift” irradiated certified and triple packed for use in critical cleanroom, RABS and Isolators aspirating heads allows a full traceability throughout the whole supply chain. The certification of sterility simplifies the activity of the laboratory and is convenient for the document inspection.
8 - IT IS CONVENIENT TO USE THE “DAILY SHIFT” FROM A COST POINT OF VIEW?
The calculation of cleaning, packaging for autoclaving, sterilisation process, certificate of sterilisation, storage of documentation, risk of un-correct certification, paper working confirm the advantage of the adoption of “Daily Shift” aspirating head. They furthermore allow time saving during periods of unusually heavy workloads.
9 - WHY IS THE TRANSPARENCY OF “DAILY SHIFT” ASPIRATING HEAD IS AN IMPORTANT ISSUE?
The transparency of the “Daily Shift” gives the possibility to the operator to control the presence of the culture agar plate.
10 - WHICH IS THE PROTOCOL FOR THE VALIDATION OF THE CONTINUOUS ENVIRONMENTAL MONITORING?
The result of counted cfu of a reference micro-organism on TSA culture plate, with and without the aspiration cycle are compared to validate the same results (with a statistical microbial contest).
11 - HOW OFTEN SHOULD THE AIR SAMPLER WITH AN AIR FLOW RATE OF 25 L/M CALIBRATED?
It is requested the traditional annual control.
12 - WHAT ABOUT THE COST OF THE MATERIAL FOR CONTINUOUS MONITORING IN COMPARISON WITH THE MEMBRANE SYSTEM OR OTHER “CLOSED” SYSTEM?
The final cost of the membrane filter or other “closed” system is higher in comparison with a normal culture agar plate as used with the TRIO.BAS. This is an important fact to consider when you take the decision to invest money for the continuous monitoring air sampler.
13 - IS IT POSSIBLE THE VISUAL RECORD OF THE COLONIES (CFU) COUNTED IN THE PETRI DISH?
Yes, using the photo-camera, in combination with the BAS software, the image of culture plate is stored for evaluation and printing.
A COMPLETE INSTRUMENT FOR ALL THE MICROBIAL ENVIRONMENTAL MONITORING NEEDES TEST





AGC air sampler consists of one instrument to sample air at 100 l/m.
The aluminum bell placed on the aspirating head allows to sample gas at 100 l/m. The technopolymer yellow bell is used to check the precision of the instrument’s flow rate.
The body of the AGC instrument is designed to stand much more stable on the surface. It is also easier for the end user to read the keyboard and, as the aspirating head is vertical, to place the plates or the bell on it. Primary applications are for pharmaceutical aseptic filling suites, cleanrooms, biotech, IVF clinics, operating theaters, hospital, pharmacies, blood banks.
It is used for active microbial air sampling.
If used for sampling the gas, the instrument works by measuring the pressure’s variation generated by air sampler while air is aspirated through an aluminum bell. A differential pressure sensor measures that variation and compares it with the reference values.
The digital control unit works as a flow meter before the gas passes through the microbial sampler.
When used to check the status of the calibration, the instrument runs by measuring the pressure’s variation generated by air sampler while air is aspirated through a technopolymer bell placed on the head of the sampler. The differential pressure sensor measures that variation and compares it with the reference values.
At the end of the test, the instrument gives the result of the test: OK if the air sampler is still calibrated, WARNING or ERROR if the air sampler is not calibrated within initial calibration specifics.
• The data can be always transferred to a PC if a dedicated software is installed.
• The transfer data can be made via Bluetooth or via cable.
• The battery is recharged by a power cable connected directly to the air sampler.
• It is possible to work either in manual or automatic mode.
• Technopolymer shockproof body with antibacterial performances of surfaces
• Stainless steel aspirating head with quick bayonet closure, identification number and stainless steel cover to prevent contaminations
• For gas test, the aluminum bell chamber and valve, the regulator are in AISI 316 rated stainless steel. The bell’s gasket is in silicon. All parts are autoclavable
• For calibration check the bell chamber is in technopolymer
• Volume of aspirated air: 100 litres/min both for air sampling and gas sampling
• Selected volumes from 30 to 2.000 litres and 17 prefixed programs
• Power supply system: the instrument can be charged continuously by AC powered source 110/240 volt 50/60 hz or by rechargeable battery (inside the air sampler)
• Battery cycles autonomy: 30.000 litres
• Language: English, French, German, Spanish, Italian
• Operative aspirating cycles: manual and automatic
• Memorized data: up to 1.000 samples
• When used as active air sampler the use of optional sterile “Daily Shift” aspirating heads reduces the risk of contamination.
• It is compact and easy to transfer.
• SOP (Standard Operating Procedure) available from Application Notes.
• Configuration of 50 users and 50 places
• Delay time, fraction time and fraction number
• Bluetooth connection or cable for data transfer to tablet or PC (with AS SW or BAS SW installed)
• Automatic next calibration reminder
• CE mark
• Continuous/trending analysis according to the USP
• Input pressure of compressed air or gas: 1 ÷ 6 bar
• Suitable for 90 mm Petri dishes or 55 mm Contact plates
• Size instrument: 303x158x135 H mm – weight 1830 gr.
• Stainless steel bell diam. 80x200 h mm – weight 1200 gr.
• Technopolymer bell chamber diam. 100x110 h mm. – weight 300 gr.
• Built in ISO 9001 premises
• IQ, OQ, PQ documentation are available
• Data integrity CFR 21 and GAMP5 (with BAS SW)
• Compliant with ISO 14698-1, EN 17141, ISO 8537-7 and FDA
(*) each pack consists of: 1 air sampler with Bluetooth and power battery charger with 1 s/s aspiration head and 1 s/s cover head, 1 compact stainless steel bell chamber with a valve and a regulator for gas pressure, 1 technopolymer bell for calibration check, 1 autoclavable tube for connecting the control unit to the bell, 1 calibration certificate, 1 cable for data transfer, 1 robustus carrying case
Single aspirating head air sampler with Bluetooth and cable for charging



• 100 or 200 litres per minute flow rate model
• Battery charger via cable (110/240 volt)
• Bluetooth for remote control of the air sampler
• Battery cycle autonomy 30.000 litres
• Manual mode only
• AISI 316 rated stainless steel aspirating head with quick bayonet closure and identification number
• Suitable for 55 mm Contact plates or 90 mm Petri dishes
• Validated according to “EN 17141”
• Main customers for TRIO.BAS MINI are agro-food industries, dairy, catering, HACCP, beverage, cosmetic, sewage treatment plant, outdoor environment, primary and secondary schools: mainly customers who make few numbers of controls.
• Bluetooth capability allows remote control of the air sampler only. Data transfer via Bluetooth is not an option with the MINI.
• The sampler is free of any external plugs and it is IP65 certified.
• Light weight, ergonomic and balanced design to facilitate handling with or without gloved hands
• Technopolymer shockproof body with antibacterial performances of surfaces
• Compliant according EN/ISO 14698-1, GMP and GLP
• Stainless steel aspirating head with quick bayonet closure, identification number and stainless steel cover to prevent contamination
• Volume of aspirated air: 100 or 200 l/m
• Selected volumes from 30 to 2.000 litres and 17 preset programs
• The aspirating chamber is suitable for 55 mm Contact plates or 90 mm Petri dishes
• Auto calibration: power/flow electronic real time control
• Battery cycle autonomy: 30.000 litres
152K TRIO.BAS MINI 100 Contact PACK (100 litres/min flow rate)
153K TRIO.BAS MINI 100 Petri PACK (100 litres/min flow rate)
162K TRIO.BAS MINI 200 Contact PACK (200 litres/min flow rate)
163K TRIO.BAS MINI 200 Petri PACK (200 litres/min flow rate)
• The battery is recharged by a power cable connected directly to the air sampler.
• The 200 lts/min air flow reduces the operator and sampling times.
• The led on the left side of visual display shows the sampling status according to different numbers of flashes (Waiting delay time, Sampling in progress, Sampling pause).
• IP65 certified protection from dust and water
• Power supply system: the instrument can be charged continuosly by AC powered source 110/240 Volt 50/60 Hz or by rechargeable batteries (inserted inside the air sampler)
• Language: English, French, German, Spanish, Italian
• Operative aspirating cycles: manual
• Memorized data: up to 1.000 samples
• Delayed, remote, start, simultaneous or interval sampling
• Automatic next calibration reminder
• CE mark
• Dimension: 33x16x15h cm
• Weight: 1.430 gr
• Built in ISO 9001 premises
(*) each PACK consists of: 1 TRIO.BAS MINI with a battery charger, 1 calibration certificate, 1 s/s ASPI head with s/s cover head, 1 light carrying case.





• 100 or 200 litres per minute flow rate model
• Battery charger via cable (110/240 volt)
• Bluetooth for data transfer
• Manual or automatic mode
• Official calibration certificate
• Operator/Administrator cascade passwords

• May be used for compressed gas testing in conjunction with gas system
• Stable on a work surface in a vertical position without the use of any external support
• Validated according to “EN 17141”
• Main customers are pharmaceutical aseptic filling suites, cleanroom, biotech, IVF clinic, operating theatre, hospital pharmacies, blood banks, clinic, microbiological labs, HVAC building monitoring, environmental labs, healthcare ambient monitoring and health authorities.
• A barcode module, thanks to the use of a scanner (barcode reader) with Bluetooth, automatically records the operator, place and plates used for the sampling. The data collected by the barcode reader is transmitted directly to the instrument. This solution is useful for those who already use culture plates with barcode or 2-D barcode (QR Quick Response Code). The data collected is transferred via Bluetooth from the air sampler to a PC or laptop via a dedicated software installed.
• The data is transferred via Bluetooth between the air sampler and a smartphone or tablet (Android version) and then to a PC or laptop.
• Light weight, ergonomic and balanced design to facilitate handling with or without gloved hands
• Technopolymer shockproof body with antibacterial performances of surfaces
• Compliant according EN/ISO 14698-1, GMP and GLP
• Stainless steel aspirating head with quick bayonet closure, identification number and stainless steel cover to prevent contamination
• Volume of aspirated air: 100 or 200 l/m
• Selected volumes from 30 to 2.000 litres and 17 preset programs
• The aspirating chamber is suitable for 55 mm Contact plates or 90 mm Petri dishes
• Auto calibration: power/flow electronic real time control
• Power supply system: the instrument can be charged continuosly by AC powered source 110/240 Volt 50/60 Hz or by rechargeable batteries (inserted inside the air sampler)
• Cycles battery autonomy: 30.000 litres
• The data may be transferred via cable, too. This is helpful for all companies that, due to internal policy, are not allowed to use wireless transfer.
• It is possibile to work either in manual or automatic mode.
• The sampler is IP65 certified.
• The battery is recharged by a power cable connected directly to the air sampler.
• The 200 lts/min air flow reduces the operator time and the time sampling.
• The use of sterile Daily Shift aspirating heads reduces the risk of contamination.
• The led on the left side of visual display shows the sampling status according to different numbers of flashes (Waiting delay time, Sampling in progress, Sampling pause).
• IP65 certified protection from dust and water
• Language: English, French, German, Spanish, Italian
• Manual and automatic passwords
• Operative aspirating cycles: manual and automatic
• Memorized data: up to 1.000 samples
• Configuration users and places: 50
• Delayed, remote, start sampling
• Bluetooth connection or cable for data transfer
• Automatic next calibration reminder
• Programmable for compressed gases/air
• Data integrity CFR 21 and GAMP5
• CE mark
• Dimension: 33x16x15h cm
• Weight: 1.440 gr
• Built in ISO 9001 premises
211K TRIO.BAS MONO 100 Contact PACK with cable (100 litres/min flow rate)
212K TRIO.BAS MONO 100 Petri PACK with cable (100 litres/min flow rate)
213K TRIO.BAS MONO 200 Contact PACK with cable (200 litres/min flow rate)
214K TRIO.BAS MONO 200 Petri PACK with cable (200 litres/min flow rate)
(*) each PACK consists of: 1 air sampler with Bluetooth and battery charger, 1 calibration certificate, 1 s/s ASPI head with s/s cover head, 1 cable for data transfer, 1 robustus carrying case.





• 100 litres per minute flow rate model
• Battery charger via cable (110/240 Volt)
• Bluetooth for data transfer
• Selected volumes from 30 to 2.000 litres and 17 preset programs

• HEPA filter
• Suitable for 55 mm Contact plates or 90 mm Petri dishes
• Use in horizontal or vertical position without any external support
• Validated according to “EN 17141”
• Main customers are pharmaceuticals, cleanrooms and biotech industries. The HEPA filter allows to capture the particulates.
• A barcode module, thanks to the use of a scanner (barcode reader) with Bluetooth, automatically records the operator, place and plates used for the sampling. The data collected by the barcode reader is transmitted directly to the instrument. This solution is useful for those who already use culture plates with barcode or 2-D barcode (QR Quick Response Code). The data collected is transferred via Bluetooth from the air sampler to a PC or laptop. PC or laptop request a dedicated software installed.
• The data is transferred via Bluetooth between the air sampler and a smartphone or tablet (Android version) and then to a PC or laptop.
• Light weight, ergonomic and balanced design to facilitate handling with or without gloved hands
• Technopolymer shockproof body with antibacterial performances of surfaces
• Compliant according EN/ISO 14698-1, GMP and GLP
• Stainless steel aspirating head with quick bayonet closure, identification number and stainless steel cover to prevent contamination
• Volume of aspirated air: 100 l/m
• Selected volumes from 30 to 2.000 litres and 17 preset programs
• The aspirating chamber is suitable for 55 mm Contact plates or 90 mm Petri dishes
• HEPA filter
• Auto calibration: power/flow electronic real time control
• Power supply system: the instrument can be charged continuosly by AC powered source 110/240 Volt 50/60 Hz or by rechargeable batteries (inserted inside the air sampler)
• The data may be transferred via cable, too. This is helpful for all companies that, due to internal policy, are not allowed to use wireless transfer.
• It is possibile to work either in manual or automatic mode.
• The sampler is IP65 certified.
• The battery is recharged by a power cable connected directly to the air sampler.
• The use of sterile "Daily Shift" aspirating heads reduces the risk of contamination.
• The led on the left side of visual display shows the sampling status according to different numbers of flashes (Waiting delay time, Sampling in progress, Sampling pause).
• Cycles battery autonomy: 30.000 litres
• IP65 certified protection from dust and water
• Language: English, French, German, Spanish, Italian
• Manual and automatic passwords
• Operative aspirating cycles: manual and automatic
• Memorized data: up to 1.000 sampler
• Configuration users and places: 50
• Delayed, remote, start, simultaneous or interval sampling
• Bluetooth connection or cable for data transfer
• Automatic next calibration reminder
• Data integrity CFR 21 and GAMP5
• CE mark
• Dimension: 33x16x15h cm
• Weight: 1.440 gr
• Built in ISO 9001 premises
170K TRIO.BAS MONO Filter 100 Petri PACK with Cable (100 litres/min flow rate)
171K TRIO.BAS MONO Filter 100 Contact PACK with Cable (100 litres/min flow rate)
173 Sterile HEPA Filter - highly efficient, single use, bidirectional bacterial/viral removal filter. (10xbox)
(*) each PACK consists of: 1 air sampler with Bluetooth and battery charger, 1 calibration certificate, 1 box Hepa Filter, 1 s/s ASPI head with s/s cover head, 1 robustus carrying case, 1 cable for transfer data.



Single aspirating head air sampler with Bluetooth and battery induction charger


• 100 or 200 litres per minute flow rate model
• The base station induction charger could be replaced by “SELFTEST SYSTEM” to verify the correct flow rate at regular intervals
• VERITEST is another independent option device to monitor the correct flow rate at regular intervals
• May be used for compressed gas testing in conjunction with gas system
• Manual or automatic mode
• Stable on a work surface in a vertical position without the use of any external support
• AISI 316 rated stainless steel aspirating head with quick bayonet closure and identification number
• Suitable for 55 mm Contact plates or 90 mm Petri dishes
• Validated according to “EN 17141”
• Main customers are pharmaceutical aseptic filling suites, cleanroom, biotech, IVF clinic, operating theatre, hospital pharmacies, blood banks, clinic, microbiological labs, HVAC building monitoring, environmental labs, healthcare ambient monitoring and health authorities.
• A barcode module, thanks to the use of a scanner (barcode reader) with Bluetooth, automatically records the operator, place and plates used for the sampling. The data collected by the barcode reader is transmitted directly to the instrument. This solution is useful for those who already use culture plates with barcode or 2-D barcode (QR Quick Response Code). The data collected is transferred via Bluetooth from the air sampler to a PC or laptop via a dedicated software installed.
• The data is transferred via Bluetooth between the air sampler
• Light weight, ergonomic and balanced design to facilitate handling with or without gloved hands
• Technopolymer shockproof body with antibacterial performances of surfaces
• Compliant according EN/ISO 14698-1, GMP and GLP
• Stainless steel aspirating head with quick bayonet closure, identification number and stainless steel cover to prevent contamination
• Volume of aspirated air: 100 or 200 l/m
• Selected volumes from 30 to 2.000 litres and 17 preset programs
• The aspirating chamber is suitable for 55 mm Contact plates or 90 mm Petri dishes
• Auto calibration: power/flow electronic real time control
• Cycles battery autonomy: 30.000 litres
• IP65 certified protection from dust and water
200K TRIO.BAS MONO 100 Contact PACK (100 litres/min flow rate)
201K TRIO.BAS MONO 100 Petri PACK (100 litres/min flow rate)
205K TRIO.BAS MONO 200 Contact PACK (200 litres/min flow rate)
206K TRIO.BAS MONO 200 Petri PACK (200 litres/min flow rate)
and a smartphone or tablet (Android version) and then to a PC or laptop.
• It is possibile to work either in manual or automatic mode.
• The air sampler is IP65 certified.
• The battery is recharged by a base station induction charger without any cable connection between the air sampler and the charger.
• The 200 lts/min air flow reduces the operator time and the time sampling.
• The use of sterile "Daily Shift" aspirating heads reduces the risk of contamination.
• The led on the left side of visual display shows the sampling status according to different numbers of flashes (Waiting delay time, Sampling in progress, Sampling pause).
• Language: English, French, German, Spanish, Italian
• Manual and automatic passwords
• Operative aspirating cycles: manual and automatic
• Memorized data: up to 1.000 samples
• Configuration users and places: 50
• Delayed, remote, start, simultaneous or sampling interval
• Bluetooth connection for data transfer
• Automatic next calibration reminder
• Programmable for compressed gases/air
• Data integrity CFR 21 and GAMP5
• CE mark
• Dimension: 33x16x15h cm
• Weight: 1.440 gr
• Built in ISO 9001 premises
(*) each PACK consists of: 1 air sampler with Bluetooth, 1 calibration certificate, 1 base station induction charger, 1 s/s ASPI head with s/s cover head, 1 robustus carrying case.



A stationary and portable single aspirating head with Bluetooth capability and cable for charging

• Stable on a work surface in a vertical position without the use of any external support
• Ideally positioned for monitoring laminar air flow systems
• 100 or 200 litres per minute air flow
• Clear easy-to-read visual display
• Battery charger via cable (110/240 volt)
• Bluetooth capability for data transfer
• Cable for data transfer


• Sample up to 30.000 litres on a fully charged battery
• Suitable for 55 mm Contact plates or 90 mm Petri dishes
• Up to 1.000 memorized data
• Save sampling time (200 litres) by doubling the aspirated volume of air
• May be used for compressed gas testing in conjunction with GAS SYSTEM (optional)
• Validated according to “EN 17141”
• This air sampler is especially dedicated to customers who make a large number of controls, in different environments, with a large staff rotation in compliance with quality standards and QM/GMP.
• Primary applications are for pharmaceutical asepting filling suites, cleanrooms, biotech, IVF clinics, operating theaters, hospital, pharmacies, blood banks, clinical microbiological labs, HVAC systems monitoring, environmental labs.
• An optional barcode module, via the use of a scanner (barcode reader) with Bluetooth, automatically records the operator, place and plates used for the sampling. The data collected by the barcode reader is transmitted directly to the instrument. This solution is useful for those who already use culture plates with barcode or 2-D barcode (QR Quick Response Code).
• The data is transferred via Bluetooth between the air sampler and a smartphone or tablet (Android version) and then to a PC or laptop, via a dedicated sotware installed.
• Technopolymer shockproof body with antibacterial performances of surfaces
• Compliant according to EN/ISO 14698-1, GMP and GLP
• Stainless steel aspirating head with quick bayonet closure, identification number and stainless steel cover to prevent contaminations
• Volume of aspirated air: 100 or 200 lt/m
• Selected volumes from 30 to 2.000 litres and 17 prefixed programs
• The aspirating chamber is suitable for 55 mm Contact plate or 90 mm Petri dish
• Auto calibration: power/flow electronic real time control
• Power supply system: the instrument can be charged continuously by AC powered source 110/240 volt 50/60 hz or by rechargeable battery (inserted inside the air sampler)
• Battery cycles autonomy: 30.000 litres
• IP65 protection certificate from dust and water
• The data may be transferred via cable, too. This is helpful for all companies that, due to internal policy, are not allowed to use wireless transfer.
• The battery is recharged by a power cable connected directly to the air sampler.
• It is possible to work either in manual or automatic mode.
• The 200 lts/min air flow reduces the operators and time sampling.
• The use of optional sterile “Daily Shift” aspirating heads reduces the risk of contamination.
• Possibility to have the version with external HEPA filter that allows to retain the particulates.
• The led on the left side of visual display shows the sampling status according to different numbers of flashes (Waiting delay time, Sampling in progress, Sampling pause).
• Language: English, French, German, Spanish, Italian
• Manual and automatic passwords
• Operative aspirating cycles: manual and automatic
• Memorized data: up to 1.000 samples
• Configuration users and places: 50
• Delayed, remote, start, simultaneous or interval sampling
• Bluetooth connection or cable for data transfer
• Automatic next calibration reminder.
• Data integrity CFR 21 and GAMP5
• CE mark
• Continuous/trending analysis according to the USP
• Dimension: 15x15x24h cm
• Weight:1600 gr.
• Built in ISO 9001 premises
445K AIRBIO ONE 100 Contact PACK with cable (100 litres/min flow rate)
446K AIRBIO ONE 100 Petri PACK with cable (100 litres/min flow rate)
447K AIRBIO ONE 200 Contact PACK with cable (200 litres/min flow rate)
448K AIRBIO ONE 200 Petri PACK with cable (200 litres/min flow rate)
(**) each pack consists of: 1 air sampler with Bluetooth and power battery charger, 1 s/s aspiration head with s/s cover head, 1 calibrate certificate, 1 cable for data transfer, 1 robustus carrying case.



A stationary and portable single aspirating head air sampler with Bluetooth, cable for charging and HEPA Filter

• 100 litres per minute flow rate model
• Battery charger via cable (110/240 Volt)
• Selected volumes from 30 to 2.000 litres and 17 preset programs
• Bluetooth for data transfer

• HEPA filter
• Suitable for 55 mm Contact plates or 90 mm Petri dishes
• Validated according to “EN 17141”
• Main customers are pharmaceuticals, cleanrooms and biotech industries. The HEPA filter allows to capture the particulates.
• A barcode module, thanks to the use of a scanner (barcode reader) with Bluetooth, automatically records the operator, place and plates used for the sampling. The data collected by the barcode reader is transmitted directly to the instrument. This solution is useful for those who already use culture plates with barcode or 2-D barcode (QR Quick Response Code). The data collected is transferred via Bluetooth from the air sampler to a PC or laptop. PC or laptop request a dedicated software installed.
• The data is transferred via Bluetooth between the air sampler and a smartphone or tablet (Android version) and then to a PC or laptop.
• Light weight, ergonomic and balanced design to facilitate handling with or without gloved hands
• Technopolymer shockproof body with antibacterial performances of surfaces
• Compliant according EN/ISO 14698-1, GMP and GLP
• Stainless steel aspirating head with quick bayonet closure, identification number and stainless steel cover to prevent contamination
• Volume of aspirated air: 100 l/m
• Selected volumes from 30 to 2.000 litres and 17 preset programs
• The aspirating chamber is suitable for 55 mm Contact plates or 90 mm Petri dishes
• HEPA filter
• Auto calibration: power/flow electronic real time control
• Power supply system: the instrument can be charged continuosly by AC powered source 110/240 Volt 50/60 Hz or by rechargeable batteries (inserted inside the air sampler)
• The data may be transferred via cable, too. This is helpful for all companies that, due to internal policy, are not allowed to use wireless transfer.
• It is possibile to work either in manual or automatic mode.
• The sampler is IP65 certified.
• The battery is recharged by a power cable connected directly to the air sampler.
• The use of sterile "Daily Shift" aspirating heads reduces the risk of contamination.
• Cycles battery autonomy: 30.000 litres
• IP65 certified protection from dust and water
• Language: English, French, German, Spanish, Italian
• Manual and automatic passwords
• Operative aspirating cycles: manual and automatic
• Memorized data: up to 1.000 sampler
• Configuration users and places: 50
• Delayed, remote, start, simultaneous or interval sampling
• Bluetooth connection or cable for data transfer
• Automatic next calibration reminder
• Data integrity CFR 21 and GAMP5
• CE mark
• Dimension: 33x16x15h cm
• Weight: 1.440 gr
• Built in ISO 9001 premises
449K AIRBIO ONE Filter 100 Petri PACK with Cable (100 litres/min flow rate)
450K AIRBIO ONE Filter 100 Contact PACK with Cable (100 litres/min flow rate)
173 Sterile HEPA Filter - highly efficient, single use, bidirectional bacterial/viral removal filter. (10xbox)
(*) each PACK consists of: 1 air sampler with Bluetooth and battery charger, 1 calibration certificate, 1 box Hepa Filter, 1 s/s ASPI head with s/s cover head, 1 robustus carrying case, 1 cable for transfer data.





AIRBIO ONE RAPID-VIRUS is an innovative instrument for airborne viable particle sampling. It is specifically designed for total pathogen monitoring of virus, bacteria, molds and yeast. The instrument has 2 different applications:
1) for collecting virus in a liquid sample for subsequent rapid analytical identification (by PCR)
2) for traditional impact on agar culture media plate to count colonies (CFU)
The collection of micro-organisms and virus on culture media requires time for incubation before results. Instead, much faster results are obtained applying the liquid collection method.
This method has great advantages when applied in the following fields:
• Industrial segment (pharma, agro-food, beverage, etc.) for a quick reaction in identifying the contamination
• Military branches for notifying possible biological attacks
• Hospitals for finding the correct pharmacological product and treatment for patients
• Public institutes (school, restaurant, bar, metro, train, municipality buildings, etc.) for disease/pandemic monitoring
AIRBIO RAPID-VIRUS also allows a quick assessment of the disinfection protocols' efficacy. The instrument is the result of the European NATO project EUCLID CEPA 13 (“protection of personnel against pathogenic micro-organisms via air sampling and rapid detection and identification”).
Principle: the volume of air is aspirated and mixed in a pre-analytical liquid.
• The collection liquid system is completely sterilizable as produced in stainless steel
• Collection liquid: water, buffer, nutrient broth
• Quantity of collection liquid: 15 ml
• Battery autonomy: 70.000 litres
• 50 users and 50 places
• Dimension of the instrument: 15x20x33h cm
• Weight: 1.850 gr
• Battery: power supply - 218 VDC 60W
• Operating conditions: T° 0-45°C / RH 10% / 60%
Code AIRBIO ONE RAPID-VIRUS
2448K
AIRBIO ONE RAPID-VIRUS PACK consisting of: AIRBIO ONE air sampler 200 l/m, 1 s/s Petri aspirating head with s/s cover head, 1 s/s collection liquid system for virus, 2 conical bottom centrifuge tube PP (225 ml), battery charger, 1 calibration certificate and 1 robustus carrying case.
Accessory
324 Conical bottom centrifuge tube PP - 225 ml (8 x box)
413 Self-sealing sterilization bag for s/s collection liquid system for AIRBIO RAPID-VIRUS (100 x box)
325 Collecting liquid system by PCR for AIRBIO VIRUS
329 VIRUS rack for conical tube PP - size 205x135x102 mm
Principle: the volume of air is aspirated on a culture media
• Air flow 200 l/m
• Battery autonomy: 70.000 litres
• 50 users and 50 places
• Dimension of the instrument: 15x15x24h cm
• Weight: 1.600 gr
• Battery: power supply - 218 VDC 60W
• Operating conditions: T° 0-45°C / RH 10% / 60%


1. Remove the s/s aspirating head and cover head from AIRBIO ONE

3. Take out the conical tube from the collection liquid system

5. The instrument is ready

7. When the sample is finished, transfer the conical tube to the laboratory for analysis

2. Position the collection liquid system into the AIRBIO ONE RAPID-VIRUS

4. Fill in the liquid in the tube

6. On the air sampler, select VIRUS under SPECIAL SAMPLING menu and press START

1 2 3 4
AIR SAMPLING STRATEGY: place, time, frequency according to validated SOP
AIR SAMPLER PREPARATION: volume of air and type of liquid according to the analytical laboratory
AIR SAMPLER PROGRAMMING: air sampler protocol according to user manual and validated SOP
5 6
SAMPLES: PCR test, qPCR RT, qPCR
AIR SAMPLER DECONTAMINATION: use 70% isopropyl alcohol
NEW SAMPLE: the air sampler is ready for a new test
Sampling air volumes
The suggested volume of air is 2.000 liters.
The air sampler has an autonomy of 70.000 litres, but it could be more whist connected to the main power.
Sampling place
Sampling Protocol
Collection liquid
Sample Storage
Sample transfer
Sample processing
The air sampler should be positioned on the direction of the air flow (between door and windows, close to the air conditioning system of HVAC). In hospital, the sampler should be placed near to patient’s bed, in public spaces where there is the highest concentration of people.
A specific SOP (Standard Operative Procedure) needs to be prepared.
The most common used liquid is phosphate buffer or saline buffer. The volume should be 15 ml. In case the aspirating time is longer, it should be necessary to add sterile water to PBS to avoid salt concentration.
If the analytical sample is not processed right away, the sample needs to be stored at +4°C.
The sample should be transferred at +4°C unless different indications from analytical laboratory.
Some protocols indicate a concentration’s step (by tangential flow filtration).





STATIM LAB is the first ISO/EIC 17025:2017 accredited laboratory that carries out calibrations of microbiological air
samplers for flow rates
of
100 l/m, 180 l/m and 200 l/m.
STATIM LAB is an Italian metrological laboratory, a division of the ORUM INTERNATIONAL company.
The laboratory was accredited ISO/EIC 17025:2017 by the American company Perry Johnson Laboratory Accreditation, Inc. (PJLA).
It is the first ISO 17025 accredited laboratory in Italy that carries out calibrations of 100/180/200 l/m flow rates of microbiological air samplers.
ISO/IEC 17025 accredited calibration is the most correct option if the microbiological air sampler is used in regulated industries (Pharma, Medical device, ect…) and where quality standards require calibration in accordance with the most stringent regulations.

STATIM LAB is a division of ORUM INTERNATIONAL, manufacturer of the TRIO.BAS air samplers.
In addition to the TRIO.BAS air microbiological samplers, the laboratory is capable of performing professional calibration services for instruments of any brand, whether they are currently in production or out of production.
The experience in the production, calibration and service of microbiological air samplers has allowed the development of a new system – “patent pending” – with very high precision, capable of directly measuring the air flow of instruments and with a reduced measurement uncertainty.
STATIM LAB guarantees calibration periods of 2/3 days.
STATIM LAB
division of Orum International S.r.l.

via Novara 89, 20153 Milano
https://www.statimlab.com/
Two aspirating heads air sampler with Bluetooth and cable for charging


• 100 or 200 litres per minute flow rate model
• Bluetooth for data transfer
• Cable for battery charger
• Cable for data transfer
• Stable on a work surface in a vertical position without the use of any external support
• AISI 316 rated stainless steel aspirating head with quick bayonet closure and identification number

• Suitable for 55 mm Contact plates or 90 mm Petri dishes
• Up to 1.000 memorized data
• Use more than one different culture media at the same time
• Saved sampling time by doubling the aspirated volume of air
• Validated according to “EN 17141”
• This air sampler is especially dedicated to customers who make a large number of controls, in different environments, with a large staff rotation and in compliance with quality standards and QM/GMP.
• Main customers are pharmaceutical aseptic filling suites, cleanroom, biotech, IVF clinic, operating theatre, hospital pharmacies, blood banks, clinic, microbiological labs, HVAC building monitoring, environmental labs, healthcare ambient monitoring and health authorities.
• A barcode module, thanks to the use of a scanner (barcode reader) with Bluetooth, automatically records the operator, place and plates used for the sampling. The data collected by the barcode reader are transmitted directly to the instrument. This solution is useful for those who already use culture plates with barcode or 2-D barcode (QR Quick Response Code).
• The data is transferred via Bluetooth between the air sampler and a smartphone or tablet (Android version) and then to a PC or laptop.
• The data may be transferred via cable, too. This is helpful for all companies that, due to internal policy, are not allowed to use wireless
• Light weight, ergonomic and balanced design to facilitate handling with or without gloved hands
• Technopolymer shockproof body with antibacterial performances of surfaces
• Compliant according EN/ISO 14698-1, GMP and GLP
• Stainless steel aspirating head with quick bayonet closure, identification number and stainless steel cover to prevent contamination
• Volume of aspirated air: 100 or 200 l/m
• Selected volumes from 30 to 2.000 litres and 17 preset programs
• The aspirating chamber is suitable for 55 mm Contact plates or 90 mm Petri dishes
• Auto calibration: power/flow electronic real time control
• Power supply system: the instrument can be charged continuosly by AC powered source 110/240 Volt 50/60 Hz or by rechargeable batteries (inserted inside the air sampler)
• Battery cycle autonomy: 70.000 litres
transfer.
• It is possibile to work either in manual or automatic mode.
• The sampler is IP65 certified.
• The battery is recharged by a power cable connected directly to the air sampler.
• The 200 lts/min air flow reduces the operator time and the time sampling.
• The use of sterile "Daily Shift" aspirating heads reduces the risk of contamination.
• The possibility to use 2 different aspirating heads allows the use of 2 different culture media at the same time or the ability to sample BEFORE (at rest), DURING (in operation) and at the END of each processing cycle.
• The led on the left side of visual display shows the sampling status according to different numbers of flashes (Waiting delay time, Sampling in progress, Sampling pause).
• IP65 certified protection from dust and water
• Language: English, French, German, Spanish, Italian
• Manual and automatic passwords
• Operative aspirating cycles: manual and automatic
• Memorized data: up to 1.000 samples
• Configuration users and places: 50
• Delayed, remote, start, simultaneous or interval sampling
• Bluetooth connection or cable for data transfer
• Automatic next calibration reminder
• Programmable for compressed gases/air
• Data integrity CFR 21 and GAMP5
• CE mark
• Continuous/trending analysis according to the USP
• Dimension: 26x28x15h cm
• Weight: 1.630 gr
• Built in ISO 9001 premises
222K TRIO.BAS DUO 100 Contact PACK with cable (100 litres/min flow rate)
223K TRIO.BAS DUO 100 Petri PACK with cable (100 litres/min flow rate)
231K TRIO.BAS DUO 200 Contact PACK with cable (200 litres/min flow rate)
232K TRIO.BAS DUO 200 Petri PACK with cable (200 litres/min flow rate)
(*) each PACK consists of: 1 air sampler with Bluetooth and battery charger, 1 calibration certificate, 2 s/s ASPI head with s/s cover head, 1 cable for transfer data, 1 robustus carrying case.



Two aspirating heads air sampler with Bluetooth and battery induction charger


• 100 or 200 litres per minute flow rate model
• The base station induction charger could be replaced by “SELFTEST SYSTEM” to verify the correct flow rate at regular intervals
• Stable on a work surface in a vertical position without the use of any external support
• AISI 316 rated stainless steel aspirating head with quick bayonet closure and identification number

• Suitable for 55 mm Contact plates or 90 mm Petri dishes
• Bluetooth capability for data transfer
• Up to 1.000 memorized data
• Use more than one different culture media at the same time
• Saved sampling time by doubling the aspirated volume of air
• Validated according to “EN 17141”
• This air sampler is especially dedicated to customers who make a large number of controls, in different environments, with a large staff rotation and comply with the quality standards and QM/GMP.
• Main customers are pharmaceutical aseptic filling suites, cleanroom, biotech, IVF clinic, operating theatre, hospital pharmacies, blood banks, clinic, microbiological labs, HVAC building monitoring, environmental labs, healthcare ambient monitoring and health authorities.
• A barcode module, thanks to the use of a scanner (barcode reader) with Bluetooth, automatically records the operator, place and plates used for the sampling. The data collected by the barcode reader is transmitted directly to the instrument. This solution is useful for those who already use culture plates with barcode or 2-D barcode (QR Quick Response Code).
• The data is transferred via Bluetooth between the air sampler and a smartphone or tablet (Android version) and then to a PC or laptop.
• Light weight, ergonomic and balanced design to facilitate handling with or without gloved hands
• Technopolymer shockproof body with antibacterial performances of surfaces
• Compliant according EN/ISO 14698-1, GMP and GLP
• Stainless steel aspirating head with quick bayonet closure, identification number and stainless steel cover to prevent contamination
• Volume of aspirated air: 100 or 200 l/m
• Selected volumes from 30 to 2.000 litres and 17 preset programs
• The aspirating chamber is suitable for 55 mm Contact plates or 90 mm Petri dishes
• Auto calibration: power/flow electronic real time control
• Battery cycle autonomy: 60.000/70.000 litres
• IP65 protection certified from dust and water
• Language: English, French, German, Spanish, Italian
220K TRIO.BAS DUO 100 Contact PACK (100 litres/min flow rate)
221K TRIO.BAS DUO 100 Petri PACK (100 litres/min flow rate)
225K TRIO.BAS DUO 200 Contact PACK (200 litres/min flow rate)
226K TRIO.BAS DUO 200 Petri PACK (200 litres/min flow rate)
• It is possibile to work either in manual or automatic mode.
• The sampler is IP65 certified.
• The battery is recharged by a base station induction charger without any cable connection between the air sampler and the charger
• The 200 lts/min air flow reduces the operator time and the time sampling.
• The use of sterile "Daily Shift" aspirating heads reduces the risk of contamination.
• The possibility to use 2 different aspirating heads allows to have 2 different culture media at the same time or the ability to sample BEFORE (at rest), DURING (in operation) and at the END of each processing cycle.
• The led on the left side of visual display shows the sampling status according to different numbers of flashes (Waiting delay time, Sampling in progress, Sampling pause).
• Manual and automatic passwords
• Operative aspirating cycles: manual and automatic
• Memorized data: up to 1.000 samples
• Configuration users and places: 50
• Delayed, remote, start, simultaneous or interval sampling
• Bluetooth connection for data transfer
• Automatic next calibration reminder
• Programmable for compressed gases/air
• Data integrity CFR 21 and GAMP5
• CE mark
• Continuous/trending analysis according to the USP
• Dimension: 26x28x15h cm
• Weight: 1.630 gr
• Built in ISO 9001 premises
(*) each PACK consists of: 1 air sampler with Bluetooth and 1 calibration certificate, 1 base station induction charger, 2 s/s ASPI head with s/s cover head, 1 robustus carrying case.



A stationary and portable two aspirating heads air sampler with Bluetooth capability and cable for charging

• 100 or 200 litres per minute flow rate model
• Easy display screen reading
• Battery charger via cable (110/240 volt)
• Bluetooth capability for data transfer
• Cable for data transfer
• Battery cycle autonomy up 70.000 litres
• Stable on a work surface in a vertical position without the use of any external support


• Suitable for 55 mm Contact plates or 90 mm Petri dishes
• Up to 1.000 memorized data
• More than one different culture media at the same time
• Saved sampling time by doubling the aspirated volume of air
• Validated according to “EN 17141”
• This air sampler is especially dedicated to customers who make a large number of controls, in different environments, with a large staff rotation and comply with the quality standards and QM/GMP.
• Main customers are pharmaceutical aseptic filling suites, cleanroom, biotech, IVF clinic, operating theatre, hospital pharmacies, blood banks, clinic, microbiological labs, HVAC building monitoring, environmental labs, healthcare ambient monitoring and health authorities.
• A barcode module, thanks to the use of a scanner (barcode reader) with Bluetooth, automatically records the operator, place and plates used for the sampling. The data collected by the barcode reader is transmitted directly to the instrument. This solution is useful for those who already use culture plates with barcode or 2-D barcode (QR Quick Response Code). The data collected is transferred via Bluetooth from the air sampler to a PC or laptop via a dedicated software installed.
• The data is transferred via Bluetooth between the air sampler and a
• Technopolymer body shockproof with antibacterial performances of surfaces
• Complaint according EN/ISO 14698-1, GMP and GLP
• Stainless steel aspirating head with quick bayonet closure, identification number and stainless steel cover to prevent contamination
• Volume of aspirated air: 100 or 200 l/m
• Selected volumes from 30 to 2.000 litres and 17 preset programs
• The aspirating chamber is suitable for 55 mm Contact plates or 90 mm Petri dishes
• Auto calibration: power/flow electronic real time control
• Power supply system: the instrument can be charged continuously by AC powered source 110/240 volt 50/60 hz or by rechargeable battery (inserted inside the air sampler).
• Cycles battery autonomy: 60.000/70.000 litres
• Language: English, French, German, Spanish, Italian
479K
DUO 100 Contact with cable (100 litres/min flow rate)
480K AIRBIO DUO 100 Petri with cable (100 litres/min flow rate)
481K AIRBIO DUO 200 Contact with cable (200 litres/min flow rate)
482K AIRBIO DUO 200 Petri with cable (200 litres/min flow rate)
smartphone or tablet (Android version) and then to a PC or laptop.
• It is possibile to work either in manual or automatic mode.
• The battery is recharged by a power cable connected directly to the air sampler.
• The 200 lts/min air flow reduces the operator time and the time sampling.
• The use of sterile "Daily Shift" aspirating heads reduces the risk of contamination and provides the certification of sterility requested by regulatory inspectors.
• The possibility to use 2 different aspirating heads allows to have 2 different culture media at the same time or the ability to sample BEFORE (at rest), DURING (in operation) and at the END of each processing cycle.
• The led on the left side of visual display shows the sampling status according to different numbers of flashes (Waiting delay time, Sampling in progress, Sampling pause).
• Manual and automatic passwords
• Operative aspirating cycles: manual and automatic
• Memorized data: up to 1.000 samples
• Configuration users and places: 50
• Delayed, remote, start, simultaneous or interval sampling
• Bluetooth connection or cable for data transfer
• Automatic next calibration reminder
• Data integrity CFR 21 and GAMP5
• CE mark
• Continuous/trending analysis according to the USP
• Dimension: 27x15x25h cm
• Weight: 2.300 gr
• Built in ISO 9001 premises
(*) each PACK consists of: 1 air sampler with Bluetooth and battery charger, 1 calibration certificate, 2 s/s ASPI head with s/s cover head, 1 cable for transfer data, 1 robustus carrying case.



A STATIONARY AND PORTABLE THREE ASPIRATING HEADS AIR SAMPLER WITH BLUETOOTH CAPABILITY AND CABLE FOR CHARGING

• 100 or 200 litres per minute flow rate model
• Easy display screen reading
• Battery charger via cable (110/240 volt)
• Bluetooth capability for data transfer
• Cable for data transfer
• Battery cycle autonomy up 70.000 litres
• Stable on a work surface in a vertical position without the use of any external support


• Suitable for 55 mm Contact plates or 90 mm Petri dishes
• Up to 1.000 memorized data, 100 places identification, 100 operators identification
• More than one different culture media at the same time
• Saved sampling time by doubling the air flow rate from 100 to 200 l/m
• This air sampler is especially dedicated to customers who make a large number of controls, in different environments, with a large staff rotation and comply with the quality standards and QM/GMP.
• Main customers are pharmaceutical aseptic filling suites, cleanroom, biotech, IVF clinic, operating theatre, hospital pharmacies, blood banks, clinic, microbiological labs, HVAC building monitoring, environmental labs, healthcare ambient monitoring and health authorities.
• A barcode module, thanks to the use of a scanner (barcode reader) with Bluetooth, automatically records the operator, place and plates used for the sampling. The data collected by the barcode reader is transmitted directly to the instrument. This solution is useful for those who already use culture plates with barcode or 2-D barcode (QR Quick Response Code). The data collected is transferred via Bluetooth from the air sampler to a PC or laptop via a dedicated software installed.
• Technopolymer body shockproof with antibacterial performances of surfaces
• Compliant according EN/ISO 14698-1, GMP and GLP
• Stainless steel aspirating head with quick bayonet closure, identification number and stainless steel cover to prevent contamination
• Volume of aspirated air: 100 or 200 l/m
• Selected volumes from 30 to 6.000 litres and 17 preset programs
• The aspirating chamber is suitable for 55 mm Contact plates or 90 mm Petri dishes
• Auto calibration: power/flow electronic real time control
• Power supply system: the instrument can be charged continuously by AC powered source 110/240 volt 50/60 hz or by rechargeable battery (inserted inside the air sampler).
• Cycles battery autonomy: 60.000/70.000 litres
• The data is transferred via Bluetooth between the air sampler and a smartphone or tablet (Android version) and then to a PC or laptop.
• It is possibile to work either in manual or automatic mode.
• The battery is recharged by a power cable connected directly to the air sampler.
• The 200 lts/min air flow reduces the operator time and the time sampling.
• The use of sterile "Daily Shift" aspirating heads reduces the risk of contamination and provides the certification of sterility requested by regulatory inspectors.
• The possibility to use 2 different aspirating heads allows to have 2 different culture media at the same time or the ability to sample BEFORE (at rest), DURING (in operation) and at the END of each processing cycle.
• Language: English, French, German, Spanish, Italian
• Manual and automatic passwords
• Operative aspirating cycles: manual and automatic
• Memorized data: up to 1.000 samples
• Configuration users and places: 100
• Delayed, remote, start, simultaneous or interval sampling
• Bluetooth connection or cable for data transfer
• Automatic next calibration reminder
• Data integrity CFR 21 and GAMP5
• CE mark
• Continuous/trending analysis according to the USP
• Dimension: 27x15x25h cm
• Weight: 2.300 gr
• Built in ISO 9001 premises
(*) each PACK consists of: 1 air sampler with Bluetooth and battery charger, 1 calibration certificate, 3 s/s ASPI head with s/s cover head, 1 cable for transfer data, 1 robustus carrying case.
TRIO.BAS MONO and TRIO.BAS DUO for potentially explosive environments (ATEX)
Microbial Air Samplers are used in Zone 2
Explosion Hazard areas (II 3G Ex iC IIC T4 Gc IP55)

PERFORMANCES
• Same performances as TRIO.BAS MONO and DUO
• Built in ISO 9001 premises
• Validated according to “EN 17141”


• The TRIO.BAS ATEX microbial air samplers (MONO, DUO) are built with components and production processes compliant with ATEX (explosion proof) certification
207K TRIO.BAS MONO ATEX (Explosion proof) Air sampler (100 lts/min) CONTACT 55 plate
208K TRIO.BAS MONO ATEX (Explosion proof) Air sampler (100 lts/min) PETRI 90 plate
209K TRIO.BAS MONO ATEX (Explosion proof) Air sampler (200 lts/min) CONTACT 55 plate
(**) each pack consists of: 1 TRIO.BAS MONO ATEX with Bluetooth, 1 calibration certificate, 1 base station induction charger, 1 s/s ASPI HEAD with s/s cover head, 1 robustus carrying case.

(**) each pack consists of: 1 TRIO.BAS DUO ATEX with Bluetooth, 1 calibration certificate, 1 base station induction charger, 1 s/s ASPI HEAD with s/s cover head, 1 robustus carrying case.
In some pharmaceutical and food premises the sampling and analytical instruments may operate in production areas and warehouses where are present inflammable material in form of gas, vapour, fog or mist. An explosive atmosphere may be created in presence of such substances and produces an inflammable mix, in case ignition occurs.
The instruments that operate in such environments need to meet the stringent International Directives referred as ATEX (Atmosphere Explosive) directives which are adopted to protect health and safety in the workplace when there are risks due to the presence of potentially explosive atmosphere.
Compressed gases and solvents with specific explosive characteristics are processed during industrial production can be released into the air. The same phenomenon can happen in the analytical laboratory in presence of solvents.
A dangerous explosion occurs when the combustible dust comes into contact with an ignition source like electrostatic discharge, mechanical overheating or chemical reactions or heat from the surrounding surfaces.


The dangers of dust explosions in food and beverage plants have been well publicized, but devastating accidents still take place far too often. Almost a quarter of all reported industrial dust explosions occur in the food and beverage industry. There are hazards that need to be controlled, such as those from flammable gas (fuels for ovens), flammable liquids and vapours (spirit based flavourings and cooking/coating oils).


One external command unit fabricated completely in stainlees steel connected to 1 up to 3 satellites with Bluetooth capability and cable for charging

• 100 or 200 litres per minute flow rate model
• Battery charger via cable (110/240 volt)
• Bluetooth for data transfer
• Cable connection for satellites from 5 to 20 meters
• Suitable for 55 mm Contact plates or 90 mm Petri dishes

• Cable for data transfer
• Possibility to add additional satellites
• Use more than one different culture media at the same time
• Saving sampling time by doubling the aspirated volume of air
• Validated according to “EN 17141”
• The RABS ISOLATOR and the satellites are fabricated in AISI 316 rated stainless steel.
• This air sampler is especially dedicated to customers who make a large number of controls, in different environments, with a large staff rotation in compliance with the quality standards and QM/GMP.
• Main customers are pharmaceuticals, cleanrooms and biotech industries.
• A barcode module, thanks to the use of a scanner (barcode reader) with Bluetooth, automatically records the operator, place and plates used for the sampling. The data collected by the barcode reader are transmitted directly to the instrument. This solution is useful for those who already use culture plates with barcode or 2-D barcode (QR Quick Response Code).
• The data is transferred via Bluetooth between the air sampler and a smartphone or tablet (Android version) and then to a PC or laptop.
• The data may be transferred via cable, too. This is helpful for all companies that, due to internal policy, are not allowed to use wireless transfer.
• It is possibile to work either in manual or automatic mode.
• The battery is recharged by a power cable connected directly to the air sampler.
• The 200 lts/min air flow reduces the operator time and the time sampling.
• This air sampler allows monitoring of separated cleanrooms with a single external command unit. The risk of human contamination is reduced, because the satellite units are permanently inside each cleanroom.
• The use of sterile "Daily Shift" aspirating heads reduces the risk of contamination.
• The possibility to use 1/2/3 different aspirating heads allows to have 1/2/3 different culture media at the same time or the ability to sample BEFORE (at rest), DURING (in operation) and at the END of each processing cycle.
• The led on the left side of visual display shows the sampling status according to different numbers of flashes (Waiting delay time, Sampling in progress, Sampling pause).
• AISI 316 rated stainless steel (command unit + satellite units)
• Compliant according EN/ISO 14698-1, GMP and GLP
• Stainless steel aspirating head with quick bayonet closure, identification number and stainless steel cover to prevent contamination
• Volume of aspirated air: 100 or 200 l/m
• Selected volumes from 30 to 2.000 litres and 17 preset programs
• The aspirating chamber is suitable for 55 mm Contact plates or 90 mm Petri dishes
• Auto calibration: power/flow electronic real time control
• Power supply system: the instrument can be charged continuosly by AC powered source 110/240 Volt 50/60 Hz or by rechargeable batteries (inserted inside the air sampler)
• Cycles battery autonomy: 60.000/70.000 litres
• Language: English, French, German, Spanish, Italian
• Manual and automatic passwords
• Operative aspirating cycles: manual and automatic
• Memorized data: up to 1.000 samples
• Configuration users and places: 50
• Delayed, remote, start, simultaneous or interval sampling
• Bluetooth connection or use of cable for data transfer
• Automatic next calibration reminder
• Data integrity CFR 21 and GAMP5
• CE mark
• Continuous/trending analysis according to the USP
• Dimension: 25x13x18h cm
• Weight: 3.150 gr
• Built in ISO 9001 premises
The TRIO.BAS RABS ISOLATOR is an extremely flexible instrument that can be easily adapted to any different type of isolator or RABS. There are different satellite versions:
1. Standard Stationary Satellite (code 260 - 261). These satellites are fabricated in AISI 316 rated stainless steel. It is possible to use 90 mm Petri dishes or 55 mm contact plates with stainless steel aspirating heads or sterile technopolymer “Daily Shift” aspirating he ads. All types of aspirating head to be ordered separately.
The compact satellite occupies little space inside the isolator.
Size: diameter 12 cm, height 12 cm, weight 1.170 gr. (without aspirating head).
2. Standard Stationary Satellite with HEPA filter (code 262 263). This satellite has the same features of the standard model. It is supplied with an adapter, positioned on one side, to which a HEPA filter is connected for filtering the expelled air. This format is typically used in cleanrooms. The filter's longevity depends on the frequency of the samples use. Replacement is recommended every 3/6 months. If the HEPA filter becomes clogged before this period, the sampler alarm system warns the operator that the airflow is irregular and therefore it is necessary to replace the filter.
Laterally there is a holder that allows to position the lid of the Petri dish during the sampling phase and to avoid contaminat ion during handling of the plate.
Size: diameter 12 cm, height 12 cm, weight 1260 gr.


The satellites can be connected to the control unit in different ways:
• Flexible cable (code 265) with a max extension of 5 mt. This cable is complete with 4-pin male/female connectors. On request, it is possible to supply cables with a length up to about 20 meters. This cable option is available for all satellites.
• Stainless steel wall connection (code 267). Guarantees a hermetic passage through a wall. The flexible cables are not included. Only for standard satellites.



Code TRIO.BAS
268K TRIO.BAS RABS ISOLATOR 100 Contact with 1 Satellite Pack
269K TRIO.BAS RABS ISOLATOR 100 Petri with 1 Satellite Pack
270K TRIO.BAS RABS ISOLATOR 200 Contact with 1 Satellite Pack
271K TRIO.BAS RABS ISOLATOR 200 Petri with 1 Satellite Pack
(*) each PACK consists of: 1 TRIO.BAS RABS ISOLATOR with battery charger, 1 calibration certificate, 1 s/s satellite, 1 s/s aspirating head with s/s cover head, 1 cable connection (5 mt), 1 cable for data transfer, 1 robustus medium carrying case.
260K SATELLITE UNIT Contact PACK
261K SATELLITE UNIT Petri PACK
(*) each PACK consists of: 1 s/s satellite, 1 s/s aspirating head with s/s cover head, 1 cable connection (5 mt). (**) second or third satellite to be added to basic sampler.

TRIO.BAS RABS ISOLATOR + 1
STANDARD STATIONARY SATELLITE

TRIO.BAS RABS ISOLATOR + 2
STANDARD STATIONARY SATELLITE

TRIO.BAS RABS ISOLATOR + 3
STANDARD STATIONARY SATELLITE
Air Passive, Air Active, Compressed Gas, Surface Microbial Sampling - SOP
Photo recording of cfu on culture agar plates - SOP
Trend Analysis - Evaluation of Microbial Environmental Monitoring Results - SOP
Contact plate microbiological surface sampler for clean room validation of “cps surface sampler” – SOP
“Daily Shift” microbial surface sampler - SOP
Periodical monitoring of TRIO.BAS air sampler calibration by “Selftest system” - SOP
Passive Air Sampling – Settle Method - SOP
From paper to paper-less - the correct microbial air and surface sampling in cleanroom and controlled environment according iso standard 14698-1 and iso standard 18593 - SOP
Air flow rate of active microbial air sampler checking at regular intervals - SOP
Cleaning procedures for microbial air sampler use in cleanroom - SOP
Contact plate for surface monitoring use - SOP
Disinfection / sterilizatio n of instrument for compressed gas monitoring – SOP
Compressed Gas Microbial Environmental Monitoring According ISO 8573-7 - SOP
Microbial Air Monitoring in Isolator and RABS - SOP
Direct printing of the sampling parameters of the TRIO.BAS with a Bluetooth printer - SOP
Viable Particles Detection with different Compressed Gas operating in Cleanroom - SOP
Data Integrity Good Practice (DIGP)in Microbial Environmental Monitoring - SOP
TRIO.BAS DUO use in Cleanroom - SOP
TRIO.BAS ISOLATOR use in Cleanroom - SOP
• No vacuum involved, but a simple electrical cable
• These satellites are fabricated in stainless steel AISI 316.
• The compact satellite occupies little space inside the isolator.
• Fixed location satellites can be easily mounted both horizontally and vertically.
• The TRI CLAMP coupling system makes satellite easy to assemble and disassemble for maintenance and calibration.
• The electric connection cable to the control units remains protected inside the s/s tube.
• It is possible to use 90 mm Petri dishes or 55 mm Contact plates with stainless steel aspirating heads or sterile technopolymer “Daily Shift” aspirating heads.
• All types of aspirating head to be ordered separately.
• Size: diameter 12 cm, height 12 cm, weight 1.170 gr. (without aspirating head).
320K


193
320K
321K
198/189 265


Stainless steel command unit with one aspiration head incorporated and cable for charging

• 100 or 200 litres per minute flow rate model
• Battery charger via cable (110/240 volt)
• Bluetooth capability for data transfer

• Cable for data transfer
• Suitable for 55 mm Contact plates or 90 mm Petri dishes
• Validated according to “EN 17141”
• The MULTIFLEX 1 air sampler is made in AISI 316 rated stainless steel.
• This air sampler is especially dedicated to customers who make a large number of controls, in different environments, with a large staff rotation and comply with the quality standards and QM/GMP.
• Main customers are pharmaceuticals, cleanrooms and biotech industries.
• A barcode module, thanks to the use of a scanner (barcode reader) with Bluetooth, automatically records the operator, place and plates used for the sampling. The data collected by the barcode reader is transmitted directly to the instrument. This solution is useful for those who already use culture plates with barcode or 2-D barcode (QR Quick Response Code). The data collected is transferred via Bluetooth from the air sampler to a PC or laptop via a dedicated software installed.
• The data is transferred via Bluetooth between the air sampler and a smartphone or tablet (Android version) and then to a PC or laptop.
• AISI 316 rated stainless steel
• Compliant according EN/ISO 14698-1, GMP and GLP
• Stainless steel aspirating head with quick bayonet closure, identification number and stainless steel cover to prevent contamination
• Volume of aspirated air: 100 or 200 l/m
• Selected volumes from 30 to 2.000 litres and 17 preset programs
• The aspirating chamber is suitable for 55 mm Contact plates or 90 mm Petri dishes
• Auto calibration: power/flow electronic real time control
• Power supply system: the instrument can be charged continuosly by AC powered source 110/240 Volt 50/60 Hz or by rechargeable batteries (inserted inside the air sampler)
• Cycles battery autonomy: 60.000/70.000 litres
• Language: English, French, German, Spanish, Italian
Code TRIO.BAS MULTIFLEX 1 PACK (*)
• It is possibile to work either in manual or automatic mode.
• The data may be transferred via cable, too. This is helpful for all companies that, due to internal policy, are not allowed to use wireless transfer.
• The battery is recharged by a power cable connected directly to the air sampler.
• While under charging, the air sampler can sample.
• The 200 lts/min air flow reduces the operator time and the time sampling.
• The use of sterile "Daily Shift" aspirating heads reduces the risk of contamination.
• Possibility to add one/two satellites to monitor other points in the cleanroom.
• The led on the left side of visual display shows the sampling status according to different numbers of flashes (Waiting delay time, Sampling in progress, Sampling pause).
• Manual and automatic passwords
• Operative aspirating cycles: manual and automatic
• Memorized data: up to 1.000 samples
• Configuration users and places: 50
• Delayed, remote, start, simultaneous or interval sampling
• Bluetooth connection or cable for data transfer
• Automatic next calibration reminder
• Data integrity CFR 21 and GAMP5
• CE mark
• Continuous/trending analysis according to USP
• Dimension: 25x13x18h cm
• Weight: 4100 gr
• Built in ISO 9001 premises
483K TRIO.BAS MULTIFLEX 1 100 Contact pack with cable (100 litres/min flow rate)
484K TRIO.BAS MULTIFLEX 1 100 Petri pack with cable (100 litres/min flow rate)
485K TRIO.BAS MULTIFLEX 1 200 Contact pack with cable (200 litres/min flow rate)
486K TRIO.BAS MULTIFLEX 1 200 Petri pack with cable (200 litres/min flow rate)
(*) each PACK consists of: 1 TRIO.BAS MULTIFLEX with battery charger, 1 aspirating head with s/s cover head, 1 robustus carrying case, 1 cable for data transfer, 1 calibration certificate.


One external command unit completely fabricated in stainless steel with cable for charging, connected to one fixed and two independent satellites

• 100 or 200 litres per minute flow rate model
• Battery charger via cable (110/240 volt)
• Bluetooth for data transfer
• Cable connection for satellites from 5 to 20 meters
• Cable for data transfer

• Suitable for 55 mm Contact plates or 90 mm Petri dishes
• More than one different culture media at the same time
• Saved sampling time by doubling the aspirated volume of air
• Validated according to “EN 17141”
• The MULTIFLEX 1+2 air sampler and satellites are fabricated in AISI 316 rated stainless steel.
• This air sampler is especially dedicated to customers who make a large number of controls, in different environments, with a large staff rotation in compliance with the quality standards and QM/GMP.
• Main customers are pharmaceuticals, cleanrooms and biotech industries.
• A barcode module, thanks to the use of a scanner (barcode reader) with Bluetooth, automatically records the operator, place and plates used for the sampling. The data collected by the barcode reader are transmitted directly to the instrument. This solution is useful for those who already use culture plates with barcode or 2-D barcode (QR Quick Response Code). The data collected are transferred via Bluetooth from the air sampler to a PC or laptop. PC or laptop request a dedicated software installed.
• The data is transferred via Bluetooth between the air sampler and a smartphone or tablet (Android version) and then to a PC or laptop.
• It is possibile to work either in manual or automatic mode.
• The data may be transferred via cable, too. This is helpful for all
• AISI 316 rated stainless steel
• Compliant according EN/ISO 14698-1, GMP and GLP
• Stainless steel aspirating head with quick bayonet closure, identification number and stainless steel cover to prevent contamination
• Volume of aspirated air: 100 or 200 l/m
• Selected volumes from 30 to 2.000 litres and 17 preset programs
• The aspirating chamber is suitable for 55 mm Contact plates or 90 mm Petri dishes
• Auto calibration: power/flow electronic real time control
• Power supply system: the instrument can be charged continuosly by AC powered source 110/240 Volt 50/60 Hz or by rechargeable batteries (inserted inside the air sampler)
• Cycles battery autonomy: 60.000/70.000 litres
• Language: English, French, German, Spanish, Italian
Code TRIO.BAS MULTIFLEX 1+2 PACK (*)
companies that, due to internal policy, are not allowed to use wireless transfer.
• The battery is recharged by a power cable connected directly to the air sampler.
• The 200 lts/min air flow reduces the operator time and the time sampling.
• This air sampler allows to monitor separated cleanrooms with a single external command unit. The risk of human contamination is reduced, because the satellite units are permanently inside each cleanroom.
• The use of sterile "Daily Shift" aspirating heads reduces the risk of contamination.
• The possibility to use 2/3 different aspirating heads allows to have 2/3 different culture media at the same time or to make sampling BEFORE (at rest), DURING (in operation) and at the END of each processing cycle.
• The led on the left side of visual display shows the sampling status according to different numbers of flashes (Waiting delay time, Sampling in progress, Sampling pause).
• Manual and automatic passwords
• Operative aspirating cycles: manual and automatic
• Memorized data: up to 1.000 samples
• Configuration users and places: 50
• Delayed, remote, start, simultaneous or interval sampling
• Bluetooth connection or cable for data transfer
• Automatic next calibration reminder
• Data integrity CFR 21 and GAMP5
• CE mark
• Continuous/trending analysis according to USP
• Dimension: 25x13x18h cm
• Weight: 4100 gr
• Built in ISO 9001 premises
474K TRIO.BAS MULTIFLEX 1+2 100 Contact with cable (100 litres/min flow rate)
475K TRIO.BAS MULTIFLEX 1+2 100 Petri with cable (100 litres/min flow rate)
476K TRIO.BAS MULTIFLEX 1+2 200 Contact with cable (200 litres/min flow rate)
477K TRIO.BAS MULTIFLEX 1+2 200 Petri with cable (200 litres/min flow rate)
(*) each PACK consists of: 1 TRIO.BAS MULTIFLEX 1 PACK, 1 calibration certificate, 2 s/s satellite, 2 s/s aspirating head with s/s cover head, 2 cable connection (5 mt), 1 robustus carrying case.



REMOTE STAINLESS STEEL TRI CLAMP ASPIRATING FUNNEL SYSTEM microbial active air sampling

ORUM INTERNATIONAL
© ALL RIGHTS RESERVED

Air Sampler
This modular system, customized according to the customer’s equipment and needs, is particularly useful when there limited space inside ISOLATOR cabinets or RABS.
TRI CLAMPS are one of the most common types of pipe connections in the Biotech and Pharmaceutical industries.
The command unit (TRIO.BAS, AIRBIO, MULTIFLEX) which is generally outside of the cabinet or outside/inside cleanrooms, programs the sampler. The operator must insert the culture media plate into the aspirating chamber of the instrument.
Validated according to “EN 17141”
This sampling system is completely fabricated in AISI 316 rated stainless steel. The TRI CLAMP connection simplifies all the cle aning/sterilization operations.The risk of contamination associated with operator activities is reduced. The Remote Aspirating Funnel can be manipu lated in multiple directions. The Remote Funnel System is fully sterilizable.
Code Individual Components:
181
REMOTE FUNNEL SYSTEM – s/s aspirating funnel end clamp with s/s aspirating bell and tube end clamp to connect the system to an Air Sampler
193 s/s TRI CLAMP with silicone gasket
194 s/s tube with 2 clamps end - 10 cm lenght
194/1 s/s tube with 2 clamps end - 20 cm lenght
194/2 s/s tube with 2 clamps end - 50 cm lenght
186 gasket for TRI CLAMP
187 s/s TRI CLAMP closing cap
188 s/s elbow short tube 90° with 2 clamps end - size wheelbase 40 mm
195 s/s elbow 90° tube with 2 clamps end - size wheelbase 88,90 mm, radius 25,40 mm
198 s/s WALL CONNECTION with 2 clamps end (wall >5
189 s/s WALL CONNECTION with 2 clamps end (wall <5 mm)




KEY WORDS
Agar plate, Aspirating head, Contamination, Isokinetic sampling, Remote sampling, Viable routine monitoring
INTRODUCTION
The REMOTE SAMPLING is necessary for viable routine monitoring because the introduction of a complete air sampler in the working area reduces the space, could increase the risk of contamination during the manipulation and the exhaust of the sampler can disrupt the laminar flow.
It is therefore suggested to adopt a “REMOTE SYSTEM” for the viable routine monitoring.
The REMOTE SYSTEM has three different possibilities.
• The aspirating funnel probe system (also called isokinetic probe) or
• The aspirating head system
• The disposable sterile system

The agar plate is outside from the cabinet

The agar plate is inside the cabinet
• The aspirating funnel probe (FIGURE 1) has the advantage of space reduction thanks to the limited dimension, the elimination of agar plate introduction in the cabinet avoiding a possible contamination during the manipulation of operator.
• The negative points are the possible partial viable particles loss from the funnel to command unit inside the transfer tubing.
• The aspirating head (FIGURE 2) has the advantage of the agar plate inside the cabinet for an immediate viable particle collection.
• The negative points are the involvement of operator and the more requested space.
• The disposable system (the agar plate is inside a plastic body connected with a plastic tubing to the command unit) has the advantage to be a closed system ready for use.
• The negative point is the cost and the fact the user is bounded to an unique supplier.
REMOTE STAINLESS STEEL TRI CLAMP ASPIRATING HEAD SYSTEM microbial active air sampling

ORUM
©

This modular system, customized according to the customer’s equipment and needs, is particularly useful when there is limited space inside isolator cabinets or RABS.
TRI CLAMPS are one of the most common types of pipe connections in the food, beverage, biotech, and pharmaceutical industries. This type of connection consists of a gasket compressed between two flanges which are in place with a clamp.
Validated according to “EN 17141”.
This sampling system is completely fabricated in AISI 316 rated stainless steel. Microbial sampling is programmed through the c ontrol unit (TRIO. BAS, AIRBIO, MULTIFLEX) which is generally located outside the isolator cabinet, RABS or inside/outside the cleanroom.
The operator must insert the plate with the culture media into the separated aspiration chamber. The TRI CLAMP SYSTEM simplifies all the operations of cleaning/sterilization. The risk of contamination associated with operator activities is reduced.
The aspirating chamber can be manipulated in multiple directions, according to the unidirectional airflow. The Remote Head System is fully sterilizable.
TRIO.BAS REMOTE STAINLESS STEEL TRI CLAMP
Code Individual Components:
191
192
REMOTE HEAD SYSTEM CONTACT - s/s aspi head chamber with aspirating head and 1 tube clamp end for 55 mm Contact plate
REMOTE HEAD SYSTEM PETRI - s/s aspi head chamber with aspirating head and 1 tube clamp end for 90 mm Petri plate
193 s/s tri clamp with silicone gasket
194 s/s tube with 2 clamps end - 10 cm lenght
194/1 s/s tube with 2 clamps end - 20 cm lenght
194/2 s/s tube with 2 clamps end - 50 cm lenght
186 gasket for TRI CLAMP
187 s/s TRI CLAMP closing cap
188 s/s elbow short tube 90° with 2 clamps end - size wheelbase 40 mm
195 s/s elbow 90° tube with 2 clamps end - size wheelbase 88,90 mm, radius 25,40 mm
198 s/s wall connection with 2 clamps end (wall >5 mm)
197 s/s hexagonal pipe hook with gaskets and adaptor
199 s/s floor pole - diameter 25 cm, 1 mt height
184 silicone tube with 2 clamps ends - 50 cm lenght
185 silicone tube with 2 clamps ends - 100 cm lenght
189 s/s WALL CONNECTION with 2 Clamps end (wall <5 mm)
(*) different sizes on request





STATIM LAB is the first ISO/EIC 17025:2017 accredited laboratory that carries out calibrations of microbiological air
samplers for flow rates
of
100 l/m, 180 l/m and 200 l/m.
STATIM LAB is an Italian metrological laboratory, a division of the ORUM INTERNATIONAL company.
The laboratory was accredited ISO/EIC 17025:2017 by the American company Perry Johnson Laboratory Accreditation, Inc. (PJLA).
It is the first ISO 17025 accredited laboratory in Italy that carries out calibrations of 100/180/200 l/m flow rates of microbiological air samplers.
ISO/IEC 17025 accredited calibration is the most correct option if the microbiological air sampler is used in regulated industries (Pharma, Medical device, ect…) and where quality standards require calibration in accordance with the most stringent regulations.

STATIM LAB is a division of ORUM INTERNATIONAL, manufacturer of the TRIO.BAS air samplers.
In addition to the TRIO.BAS air microbiological samplers, the laboratory is capable of performing professional calibration services for instruments of any brand, whether they are currently in production or out of production.
The experience in the production, calibration and service of microbiological air samplers has allowed the development of a new system – “patent pending” – with very high precision, capable of directly measuring the air flow of instruments and with a reduced measurement uncertainty.
STATIM LAB guarantees calibration periods of 2/3 days.
STATIM LAB
division of Orum International S.r.l.

via Novara 89, 20153 Milano
https://www.statimlab.com/
Induction battery charger incorporates a differential pressure device to monitor the deviation of the flow rate compared to the calibration value.

• Having at least one SELFTEST is recommended as part of your best practice to verify the correct volume of aspirated air (ok - warning - error) when sampling with single or multiple instruments

• Technopolymer aspirating bell chamber
• Base station induction battery charger
• Validated according to “EN 17141”
• The SELFTEST is a system that, instead of the auto calibration already present in the air sampler, checks the precision of the air flow rate. This check is necessary to avoid invalidation of the tests between annual controls for official certification.
• The bell chamber is connected through a tube to the base station induction battery charger.
• Main customers are GLP/GMP for pharmaceutical, cleanroom and biotech industries.
• The base station includes the power supply for charging the TRIO.BAS air sampler batteries.
• SELFTEST is only suitable for air samplers with induction chargers.
Code SELFTEST SYSTEM (*)
• This system works by measuring the depression generated by the air sampler while air is aspirated through a special lid (aspirating bell) applied to the aspirating head. A differential pressure sensor measures that depression and compares it with the set value stored in the TRIO.BAS sampler under test. The result appears at the end of the test, on the LDC of the TRIO.BAS air sampler. Results are displayed as: OK (the air sampler is calibrated), WARNING or ERROR (the air sampler is not within calibration specifics).
• The result is recorded automatically into the air sampler according to data integrity.
• Built in ISO 9001 premises
351 Base Station induction battery charger with user SELFTEST check calibration system (100 lt/min) for Contact Plate or Petri 90 mm plate
352 Base Station induction battery charger with user SELFTEST check calibration system (200 lt/min) for Contact Plate or Petri 90 mm plate



To check, at regular intervals, the precision level of air flow rate

• Aluminium aspirating bell chamber
• CE mark
• The VERITEST is a system that, instead of the auto calibration already present in the air sampler, checks the precision of the air flow rate. This check is necessary to avoid invalidation of the tests between annual controls for official certification.
• Main customers are GLP/GMP for pharmaceutical, cleanrooms and biotech industries.
• The VERITEST is a manual system thus the results need to be reported in a document validated by a quality controller.
• VERITEST is suitable for all air samplers and satellites.
• Sizes: 12,5x5h cm.
IDENTIFICATION CODE
Code VERITEST SYSTEM

• Command data unit
• Validated according to “EN 17141”
• This system works by measuring the depression generated by the air sampler while air is aspirated through a special lid (aspirating bell) applied to the aspirating head. A differential pressure sensor measures that depression and compares it with the set value stored in the TRIO.BAS sampler under test. The results appear at the end of the test, on the LCD of the TRIO.BAS air sampler. Results are displayed as: OK (the air sampler is calibrated), or WARNING or ERROR (the air sampler is not calibrated within calibration specifics).
• Built in ISO 9001 premises.
353 VERITEST - check calibration system (100 - 200 lt/min) with power supply 6VDC mA
HVAC (Heating Ventilation Air Conditioning) Microbial Hygiene Inspection
Cleanroom Air Monitoring from the Sterile Air Outlets - SOP
Microbiological Air Sampling in Food and Dairy Industries
Cleanrooms and Associated Controlled Environments – Biocontamination Control – Annex D
Evaluation of Bacteria and Moulds from HVAC System in Food/Dairy Industry
Microbial Air Sampling from HVAC Outlet
ASTM Guidelines for Bioaerosol Monitoring
Best Practices for Microbial Air Monitoring in Food, Dairy, Supermarket Premises
EFFL European Union Report Biocontam. Control in Food Cleanroom
Q&A About HVAC in Food, Dairy, Agro, Beverage Premises
The microbial content of air in production premises, warehouse, food dairy and beverage production sites is pretty important. A regular monitoring of these premises has the purpose to reduce the air bioburden in order to obtain products of better quality, less contamination, longer shelf-life, better customer satisfaction.
Tests microbiological quality of compressed air/gas used in cleanrooms. To be used with ASPI Gas chamber or TRIO.BAS instrument.
TRIOGAS Samplers can be used: Zone 2 - Explosion Hazard areas (II 3G Ex iC IIC T4 Gc IP55)

• Stainless steel calibrated valve and bell chamber
• Official calibration certificate
• Suitable for 90 mm Petri dishes or 55 mm Contact plates
• A stainless steel calibrated valve guarantees 100 litres per minute flow rate

• Completely fabricated in AISI 316 rated stainless steel
• Each component of the TRIO.GAS adaptor instrument is autoclavable with no disassembly required
• No glass valves or meters to crack or break
• Validated according to “EN 17141”
• The TRIO.GAS guarantees that product contact air is contamination free within sterile or aseptic manufacturing facilities (e.g. cleanroom).
• Main customers are pharmaceuticals, cleanrooms, food and dairy industries.
• The system is according to ISO Standard 8573-7 and ISO 14698-1.
• Before passing through a TRIO.BAS air sampler, the air flow from the compressed supply is regulated by an autoclavable flow meter.
• Made in AISI 316 rated stainless steel
• Totally sterilizable via autoclave with no disassembly required
• Volume of aspirated air: 100 litres/min
• Input pressure: 1 ÷ 6 bar
• The aspirating chamber is suitable for 90 mm Petri dishes or 55 mm Contact plates
Code TRIO.GAS SYSTEM
• All the sampling data is transferred via Bluetooth (if using a TRIO. BAS air sampler) to a tablet/smartphone or via Bluetooth to PC by downloaded dedicated software according to GMP and GLP.
• When TRIO.GAS is used in combination with a TRIO.BAS air sampler, the time is regulated by the software of the air sampler.
• When TRIO.GAS is used in combination with ASPI Gas Chamber, the test is manual and the time is regulated by a timer counter.
• Fully compliant according to ISO 8537-7 and EN/ISO 14698-1 FDA
• Dimension: 40x18x25h cm
• Weight: 5290 gr
• Built in ISO 9001 premises
600 TRIO.GAS SYSTEM complete of stainless steel electrovalve, gas connection, stainless steel fixing system for air sampler, 1 carrying case and 1 calibration certificate
452 S/S ASPI GAS CHAMBER - with ASPI HEAD CONTACT plate and cover with adapter for TRIO.GAS
453 S/S ASPI GAS CHAMBER - with ASPI HEAD PETRIplate and cover with adapter for TRIO.GAS
Note: Data must be manually recorded and sample must be timed when using ASPI Gas chamber without a TRIO.BAS instrument.


Two performances in one instrument (EASYGAS + VERITEST): compressed gas test and check of the precision level of flow rate at regular intervals

VERIGAS is a complementary instrument for TRIO.BAS air samplers.

VERIGAS consists of:
• a digital control unit with tube to connect the bells chambers.
• a stainless steel bell chamber with an on/off valve and a regulator for gas pressure test
• a technopolymer bell chamber to control the air flow rate during the routine activity VERIGAS can be used with TRIO.BAS, AIRBIO and MULTIFLEX air samplers.
• Validated according to “EN 17141”
• The system VERIGAS (EASYGAS+VERITEST) works by measuring the pressure’s variation generated by air sampler while air is aspirated through a bell-shaped aspirating chamber (in stainless steel for EASYGAS and in technopolymer for VERITEST) applied to the head of the sampler. A differential pressure sensor measures that variation and compares it with the reference values.
1. For EASYGAS the gas or air flow from compressed supply is regulated by the connected digital control unit which works as a flow meter before passing through the microbial sampler.
2. For VERITEST the result appears at the end of the test. Displayed on the control unit as: OK (the air sampler is still calibrated), or WARNING or ERROR (the air sampler is not calibrated within calibration specifics)
• The EASY GAS checks that product contact air is contamination free within sterile or aseptic manufacturing facilities like Cleanroom
• Any air sampler is easily and aseptically connected to the output of compressed gas
• For EASYGAS, the bell chamber, the valve and the regulator are in AISI 316 rated stainless steel. The bell’s gasket is in silicon. All autoclavable
• For VERITEST the bell chamber is in technopolymer
• Volume of aspirated air: 100 litres/min for EASYGAS – 100/200 litres/min for VERITEST
• Input pressure: 1 ÷ 6 bar
• Compact and easy to transfer
IDENTIFICATION
• Before entering the aspiration head of a TRIO.BAS air sampler, the air flow from the compressed supply is regulated by a flow valve
• All the sampling data are transferred via Bluetooth or cable (depending on the TRIO.BAS model used) to a PC by a dedicated software according to GMP and GLP
• 1.000 litres of compressed air/gas impact on the 90 mm agar culture Petri dish or Contact plate to collect the microorganisms
• Compliant according to ISO standard 8573-7 and ISO Standard 14698-1
• It can be used in combination with TRIO.BAS, AIRBIO and MULTIFLEX air samplers
• SOP (Standard Operating Procedure) available from Application Notes
• Suitable for 90 mm Petri dishes or 55 mm Contact plates
• Operates with a 1,5V battery (no main power connection)
• Size: command unit 120x80x80 mm
• Stainless steel bell diam. 80x200 h mm – weight 1200 gr.
• Tecnopolymer bell chamber diam. 100x110 h mm. – weight 300 gr.
• Built in ISO 9001
• I.Q., O. Q., P.Q. documentation
599 VERIGAS – for compressed gas test and air flow rate check - with digital control unit, s/s bell chamber for Easygas, technopolym er bell chamber for Veritest, connection tube and robustus carrying case


Microbiological sampler to test quality of Air/Nitrogen/CO2

• The 100 lt/min flow rate of FLUGAS System is guaranteed by a flow regulation system controlled by the operator via a calibrated flow meter.
• The system includes ASPIGAS chamber and the results are recorded manually. Optionally, the test can be performed with a TRIO.BAS 100 lt/minutes and the records are automatic.
• Validated according to “EN 17141”

• FLUGAS System consists of:
- stainless steel compact base (1);
- analogic calibrated vertical flow meter (2);
- stainless steel AISI316 bell chamber (3);
- on/off valve and a regulator for flow rate (4);
- ASPIGAS chamber with Aspirating head (5 – 6);
- digital timer (7);
- gas input to be sampled (8)
• The system is compliant with ISO Standard 8573-7 and ISO 14698.
• If the FLUGAS System is used in combination with ASPIGAS chamber, the test is manual and the time is calculated by a digital timer.
• If the FLUGAS System is used in combination with a TRIO.BAS air sampler the whole cycle of the test is programmed automatically, controlled and recorded by the software of the device. The sampling data can be transferred via cable or Bluetooth to a PC with a dedicated software according to GMP and GPL.
• All the components of the FLUGAS System are autoclavable (excluding the vertical flow meter and timer).
• Input pressure: 1 ÷ 10 bar:
- air flow 100/200 lt/min (200 l/m optional)
• Size 21x17x12H cm. (with flow meter 32,5H cm) Weight: 1,38 Kg. (with flow meter 2 kg).
Data must be manually recorded and sample must be timed when using chamber without a TRIO.BAS instrument.




Contact Plate Sampler system for surfaces

• Timer: 10 seconds
• Operating temperature: 0-40°C
• Size: diameter 95x45H mm

• Code 289
• Validated according to “EN 17141”
• TRIO.CPS is used to evaluate the correct cleaning of all surfaces in contact with food and dairy products to validate the HACCP and training of the staff.
• TRIO.CPS is used in pharma cleanrooms, biotech plants and healthcare facilities to standardize surface monitoring when using traditional irradiated culture media.
• TRIO.CPS is used in combination with the most commercial Contact plate (e.g. RODAC) diameter 55 mm: the standard weight and 10 seconds with visual display guarantee to meet the ISO 18593 for horizontal surface sampling.

Insert the timer in the TRIO.CPS
Set for 10 seconds

• The metal base guarantees easy sterilization/disinfection.
• The CFU are counted at the end of incubation and the results are reported as CFU/cm2 or CFU/culture plate.
• Ideal for use with standard culture media: Total Bacterial Count (e.g. Trypticase Soy Agar with Lecithin and Polysorbate 80) and Total Yeast and Molds Count (e.g. Sabouraud Glucose Agar with Lecithin and Polysorbate 80).

lid from 2 4 5 6
Slide the contact plate into position
Remove 4 2 6 8
Press the TRIO.CPS system to the surface to be sampled
Start the 10 seconds timer and lift up the TRIO.CPS at the conclusion of timed sample
contact plate

Apply the lid to the contact plate, remove the plate and transfer to microbiology lab

Articulate stainless steel support for Passive Air Sampling in table and floor model formats

The settle method is applied with the culture plate in a horizontal or inclined position, according to the direction of the unidirectional air flow.
In a horizontal position, air flow may be obstructed creating a slight turbulence over the surface of agar which could deviate the viable particles from the agar’s surface.
A slanted position of the Petri dish allows the air to hit the agar surface and pass by without disturbance.
TRIO.SETTLE is an articulate device developed to standardize, test, and enumerate the presence of microorganisms when applying the passive air monitoring, or settling plate, method.
Passive air sampling provides a quantitative analysis of airborne microorganisms deposited onto the surface of an agar plate over a period of exposure.
TRIO.SETTLE can be fixed on a tripod or other floor support devices.
TRIO.SETTLE is fabricated from AISI 316 stainless steel and fully autoclavable.
Validated according to “EN 17141”.
PASSIVE SAMPLING, COMBINED WITH ACTIVE SAMPLING, IS RECOGNIZED BY REGULATORY ORGANIZATIONS AS USEFUL IN ASSESSING THE MICROBIAL QUALITY OF THE AIR ENVIRONMENT.
The Active Method: a predetermined volume of air is drawn onto an agar plate at a controlled rate of speed. An active air sampler provides an estimate of the number of microorganisms impacted onto an agar plate, free-floating or carried on particles, within a given size, within a cubic meter of air.
The Passive Method: a static agar plate provides an indication of any microorganisms which might settle out of the air due to gravitational effects. Open agar plates are exposed to the environmental air for a length of time. The number of agar plates placed in the environment, and the exposure time, depends on the risk evaluation. The suggested media is Tryptic Soy Agar (TSA). The microorganism population that settles on the agar plates are counted and evaluated. Passive sampling is simpler and less expensive compared to active sampling, which requires a device. Passive sampling produces an indication of the settling microbial population; active sampling produces a reliable quantification.
CFU/Exposure time: WHO World Health Organization. The tables below are based on World Health Organization’s guide on monitoring the environment in vaccine manufacturing facilities with a maximum exposure time of 4 hours (90 mm Petri dishes).
EN 17141:2020 Cleanroom –Biocontaminaton Control
The number of CFU per plate, per time (e.g. CFU/settle plate/4 H)
The TRIO.SETTLE consists of:
• AISI316 stainless steel fabrication
• Upper surface disc to accommodate the open culture plate during sampling
• Lower surface disc to accommodate the lid of the culture plate
• Articulate system to obtain different inclinations to the agar surface related to the direction of unidirectional airflow, avoiding laminar flow turbulence
• System to fix the TRIO.SETTLE to a tripod or a base
• Floor base
The TRIO.SETTLE ideally standardizes the position of the culture plate and reduces the risk of contamination during sampling.
Annex C – C.3.3
367
368





Sterile aspirating head for TRIO.BAS air samplers to be used several times during a daily operation shift.

90
55

• The sterile Daily Shift aspirating heads (DSH - sterile Daily Shift Head) avoid the sterilization process necessary for stainless steel aspirating heads.
• The sterilization is proven by an official certificate. This document is requested by regulatory authorities.
• The double irradiated sterile packaging allows the users to always have aspirating heads ready for use.
• The transparency of the sterile Daily Shift is useful for verifying the culture plate is inserted correctly in the aspirating chamber.



• Main customers for sterile Daily Shift heads are: agro-food industries, dairy, catering, HACCP, beverage, cosmetic, sewage treatment plants, outdoor environments, primary and secondary schools, pharmaceuticals, cleanrooms, biotech, hospitals, clinics, microbiological labs, HVAC building monitoring, environmental labs, healthcare ambient monitoring, health authorities.
• They are suitable for all TRIO.BAS air samplers.
• Shelf life: 6 years from the date of sterilization.
Stainless steel Aspirating Head(s) of air samplers must be sterilized daily by autoclaving
IDENTIFICATION CODES CODE
• The double irradiated packaging reduces the risk of contamination during manipulation
• A daily certificate of sterilization is requested by regulatory authorities as part of the usual auditing process
• The use of DAILY SHIFT aspirating heads eliminates the cost of in house sterilization and the task of preparing the certificate of sterility
• DAILY SHIFT heads allow time savings during periods of unusually heavy workloads
• DAILY SHIFT heads are semitransparent to see the culture plate inside the aspiration chamber

Stainless steel Aspirating Head(s) must be sterilized daily by autoclaving

Take a look at the involved processes (one daily operative shift in Cleanroom)
STAINLESS STEEL ASPIRATION HEAD 90mm PETRI DISH - 55mm CONTACT DISH

Stainless Steel: Autoclavable, same lifetime of the air sampler, used for official calibration of the instrument and included in the standard kit.
*based

STAINLESS STEEL HEAD
DAILY TOTAL COST A+B+C+D+E= 2$+1$+3$+5$+4$=

DAILY SHIFT ASPIRATION HEAD 90mm PETRI DISH - 55mm CONTACT DISH $15*
Ready to use in the cleanroom: Double single packaging and certificate of sterilization.
STAINLESS STEEL HEAD vs READY TO USE HEAD COSTS COMPARISON
STAINLESS STEEL HEAD
$15 x 20 Working Days = $300
$300 x 10 Working Months = $3.000
READY TO USE HEAD $10*
DAILY COST READY TO USE HEAD + (E) = 8$+2$ =
*based on average cost (calculated in $) of aspirating and operator labor and time
DAILY SHIFT HEAD
$10 x 20 Working Days = $200
$200 x 10 Working Months = $2.000
CONCLUSION: “DAILY SHIFT” heads allow to save money (e.g. $1,000 in one year). It is always convenient to keep them in case of sterilization document inspection.

• Irradiated and triple packed for use in critical cleanroom, RABS and ISOLATORS.
• Individually labeled in class 7 cleanroom.
• Allow a full traceability throughout the whole supply chain.


This software is simple to use and it is suggested when the users mainly want transfer data to a PC for recording or analysis.
This software allows to download sampling data from a TRIO.BAS instrument to a PC:
• no passwords
• possibility to control the air sampler remotely
• possibility to view all samples, to filter the information, to export in “.pdf, .csv and .asd format (encrypted)
• it works with all our air samplers except for MINI
CODE AIRSAMPLER SOFTWARE
295 “AS Software” - transfer data from instrument or smartphone/tablet to PC by Bluetooth or by cable (for cable models)
300 APP Android “ASAPP” - transfer data from instrument to smartphone/tablet and to PC by Bluetooth


US FDA 21 CFR annex 11 requires the producers of drugs, medical devices, active ingredients and other types ofd industries regulated by FDA implement data control systems inside their organisational processes.
The systems which process data in an electronic format must guarantee the security, the traceability and the integrity of data. They need to satisfy some requirements including the access to the systems through individual credentials (personal password), traceability of events through audit trails, no modifiable reporting data and the documentation of the system’s specifications.
CODE AIRSAMPLER SOFTWARE

BAS Software attends all these requirements. This software is used in combinations with TRIO.BAS air samplers and, optional, with the CFU Photo Camera.
• passwords to log in
• 3 different users: root master, administrator and standard user
• possibility to give different permissions to each single user
• possibility to control the device remotely
• possibility to configure the air sampler, setting users and places directly on the software and transfer this data automatically on the air sampler
• possibility to view all samples, to filter the information, to export in different formats: .pdf, .csv, .xml and .bas (encrypted)
• it is also possible to manage different type of sampling: active, passive, surface and gas (special sampling)
296 “BAS Software” - transfer data from instrument or smartphone/tablet to PC by Bluetooth or by cable (for cable models)
302 APP Android “BASAPP” - transfer data from instrument to smartphone/tablet and to PC by Bluetooth






P.A.C.A.S. for Microbiological EM according to ISO 14698-1
P assive A ctive C ompressed A ir S urface
Passive air sampling (natural exposure of agar/settling plates), active air sampling (TRIO.BAS or AIRBIO), compressed gas sampling (TRIO.GAS), and surface sampling (TRIO.CPS) can be used in combination with BAS software and CFU Photo Camera.
The BAS software digitally manages all sampling methods (air + compressed gas + surface) in compliance with CFR21 part 11 directives, producing data of the total sampling plan.
Contact plate and Petri plate protocols are available, with the greatest advantage achieved using the same plate format for each sample type: Air (active and passive), compressed gas/air, and surface applications.









MICROBIAL AIR SAMPLER

Cleanroom operator
Transfer plates to incubator

data transfer to BAS SW via Bluetooth to PC
Cleanroom operator

COMPUTER

CFU Count and report via cable results and images to BAS SW


BAS Software Report printing
Laboratory operator


Before counting
After counting

As requested by Good Laboratory Practice and Data Integrity 21 CFR part 11, the BAS Software records culture plates’ photos immediately before and after the manual CFU count thanks to the CFU Photo Camera (code 337).
The CFU Photo Camera is connected to the PC with the BAS Software installed and the two pictures are automatically recorded and saved in the software. It is possible to export all detailed information of a single sample in a pdf file or print a paper copy.
• The CFU Photo camera must be used in combination with the BAS Software.
• Simple use: the operator connects the CFU Photo Camera to the PC (with the BAS SW installed), puts the identified culture dish with the counted signed colonies on the designated illuminated area of the CFU Photo Camera, click “Capture” button on the BAS SW to take the picture and store it.
• The pictures of the culture plate are reported at the bottom of the single report where all information of the sample are detailed.
• Light System: LED technology
• Camera resolution: full HD 1080p
• Construction: technopolymer antibacterial treatment
• Suitable for 90 Petri dishes or Contact plate
• Connection to the printer via BAS SW downloaded to PC

• The report is stored in the BAS SW and then exported in a pdf file for subsequent evaluation.
• Compliant to ISO 7218.
• The system (BAS SW and CFU Photo Camera) is developed according to the requests of the regulatory inspectors.
• The CFU Photo Camera avoids the presence of a second operator, saving additional costs.
• The price of the CFU Photo Camera is affordable and convenient for all microbiological laboratories which apply with GLP and ISO 17025.
• Power voltage: 24/220 V
• Size 17x18x29 H cm.
• Weight: 2,8 kg.
• CE mark
• Made in Italy




Simple use: the operator has just to transfer the identified culture dish with the counted signed colonies on the reading place of the TRIO. BAS CFU photo camera and press a button on the PC where the BAS software is downloaded. According to the GLP, Data Integrity, 21CFR Part 11, the results of all the analytical tests should not be modified and, in such case, it is necessary to show and justify the reason of modification.
These rules are valid for all the analytical cycle, but in the traditional microbiological laboratory the CFU count represents a “uncontrolled and not confirmed data”. The operator, after counting the colonies (CFU) of each culture plate, registers the number and then discharge the plate. There is no trace of count because the plate cannot be stored.
This fact can be solved by a sophisticated and expensive colony counter or more simply adopting a new TRIO.BAS CFU Count photo camera with the BAS software.
THE NEW PHOTO-CAMERA-PRINTER
• Photo-camera-printer system for image of culture plate recording and storing at the end of incubation and after colony counti ng.
• The image of the culture plate is presented at the bottom of the single report that summarizes the complete sampling cycle.
• The documentation can be stored in PC where is download the BAS software and transformed in PDF file for subsequent evaluation.
• In compliance with ISO 7218.
• The System has been developed according to the requests of the regulatory inspectors.
• The TRIO.BAS CFU count photo camera is used in combination with the TRIO.BAS Software.






Robust platforms which greatly improve the stability of the air sampler when vertically positioned and reduce the risk of fall or damage.
Completely made in high density impact resistant technopolymer. The shaped base allows the vertical positioning of the air sampler with the use of just one hand. They can be positioned on any work surface or on all tripods and MINI multi holder cart with wheels. Fixed on vertical tripod, the stand allows the air sampler to be independant from the vertical tripod for charging the battery or removing the plates for sampling.







370 STAND UP HOLDER FOR MINI
Size 150x110x90h mm. – weight 390 gr.
376 STAND UP HOLDER FOR MONO, DUO, TRIO
Size 145x105x85h mm. – weight 256 gr.
377 STAND UP HOLDER FOR AIRBIO
Size 165x165x70h mm. - weight 337 gr.
Size 13x10x25h cm - weight 300 gr.
Completely fabricated in AISI 316 rated stainless steel. The shaped base allows the vertical positioning of the air sampler with the use of just one hand. It can be positioned on any work surface or can be fixed on all tripods and MAXI multi holder cart with wheels. Fixed on vertical tripod, the stand allows the air sampler to be independant from the vertical tripod for charging the battery or removing the plates for sampling.
Size 21x13x16h cm - weight 700 gr. Completely fabricated in AISI 316 rated stainless steel. It can be positioned on any work surface or can be fixed onto a wall to keep the air sampler in the same direction of the air coming out from conditioned port.
The floor tripods allow for positioning the air samplers higher than work surface and orientating them differently from vertical position.

Adjustable height from 150 cm to 200 cm.
Completely made in AISI 316 rated stainless steel.
A ball joint fixes the air sampler and adjust the orientation of the air sampler. Fabricated in AISI 316 rated stainless steel to avoid particle emissions, this tripod is suitable ideally for cleanrooms. The air sampler can be fixed directly on the tripod or alternatively on a stand up holder (optional) fixed on the tripod.




BALOMETER - it is a tool to be placed on the aspirating head of the air sampler in order to convey the air coming out of the ventilation systems on the ceilings.
It consists in a funnel holder to be applied by pressure on the aspirating head and a polycarbonate funnel.
The BALOMETER comes in two sizes: diameter max 21 cm - diameter max 32 cm
Transportable and compact, the MAXI TRIPOD is an innovative floor tripod. Made from light weight aluminum, it is sturdy enough to support TRIO.BAS air sampler at great heights




• Adjustable height from min.125 cm to max 366 cm
• Completely made in anodized aluminum.



• The air sampler can be fixed directly on the tripod or alternatively on a STAND UP holder (optional) fixed on the tripod.
• Compact 4 section stand with 3 risers
• Smooth cushioning of tube movement when the tripod is raised or lowered protects your fingers
• The wide bases opens up to 107cm to keep the tripod steady
IDENTIFICATION CODE





DESCRIPTION
• The MINI cart is a good tool for cleanrooms, to move easily the air sampler and keep its accessories all together.
IDENTIFICATION CODES
• The cart is equipped with 2 shelves.
• Optional: the stand up holder or the vertical hook holder.



• The MAXI cart is a good tool for cleanrooms, to move easily the air sampler and keep its accessories all together.
• The cart is equipped with 2 shelves.
IDENTIFICATION CODES
370 376 377

The stand up holder, which is fixed on the vertical support, helps the operator to remove the air sampler for decontamination or charging the batteries. Alternatively the air sampler can be screwed directly on the vertical support.
• The vertical support allows the air sampler to reach higher sampling points. The height can be between 147 cm and 218 cm.
• Optional: the stand up holder or the vertical hook holder.
• Ideal for placement of MULTIFLEX at various heights and cleanroom points that are not easily accessible.
• Simple, stable design: The MULTIFLEX instrument easily attaches to the Holder without fixing screws.
• Fabricated in AISI 316 Steel in AISI 316 Stainless Steel.
379 s/s MULTIFLEX HOLDER – sizes: 25x14 cm.
484 s/s TRIO.BAS MULTIFLEX Command unit
372 s/s MULTI MAXI CART on wheels – adjustable height from 100 to 210 cm.




Stainless Steel for support culture plate lid and sampling head during sampling phase
Operators, and their activities, represent the greatest risk of contamination inside cleanrooms.
Operators must work under stringent conditions; required to wear special overalls, gloves, facemasks, and eye masks.
For these reasons, it is advisable to create the best possible working conditions.
Air sampling with microbiological samplers is a complex and delicate operation, whether using an instrument with a single aspirating head, or an instrument with more than one aspirating head.

• Built in AISI 316 stainless steel
• Wedge shape inclined at 150 °
• Autoclavable
• Two-sided Support
• Usable for Petri dishes, Contact plates and aspirating heads
• A single hole on one side, and two holes on the other side, facilitate identification of plates and heads
• Size: 90x120x105H mm.
• Code. 180


To facilitate operations and avoid errors and risks of contamination during the sampling phase, the TRIO.BAS IN-REST is particularly useful as a temporary support for culture media plates and/ or lids, and instrument sampling heads.

Cleanroom Stainless Steel Rack with handle for stacking, storing, and transporting culture plates (Petri or Contact plate). They are used to maintain the distance inside the incubator according the GLP* (Good Laboratory Practice).

• They can be refrigerated, incubated and autoclaved.
• Each rack can hold up to 11 Petri dishes, or 15 Contact plates.
• A wide front opening permits easy access but prevents dishes from sliding out.
• The same rack can be adjusted for Petri or Contact plate.
• Avoids all risk of accident during loading and transport to the incubator for staff bio-hazard safety.
• The weight of only 280 gr. make it light and easy to carry.
*ISO Standard and GPL request that inside the incubator the culture plates are stacked not more than six and at a distance of 2 cm.

• Wire design lets you clearly visualize culture dishes.
• Racks are fully autoclavable.

With self-adhesive tape
Sterile bags ideal for safely containing and transporting Petri dishes, Contact plates, Swabs, or other objects, outside of the cleanroom:
• Sterility Traceability.
• Triple-wrapped and individually sealed to ensure sterility.
• Beta sterilization certificate included.
• Color is easy to identify in the cleanroom.
• Write-on oversized area to identify sample contents suitable for use with permanent markers.
• Self-adhesive flap closure prevents contamination after samples are placed inside of the bag.
• Included an easy-open thear line which guarantees the sterility of the single bag.
• The elongated, flat bag design facilitates stacking of multiple bags, easy reading of bag contents, and allows plate lids to stay secured inside the bag during handling.

Protective cases are suggested to guard air sampler from damage during movement within the production environment and when sent to service centers for calibration.
The ROBUSTUS carrying cases are a very important accessory because they protect the instruments from any damage during the transport phases and especially when they have to be sent to the metrological laboratories for annual calibrations. The ROBUSTUS carrying cases are resistant to dust, water (IP67), shocks, temperature changes and vibrations during air and truck transport.
395

524


Code CARRYING CASE
392 ROBUSTUS LARGE carrying case for TRIO.BAS MULTIFLEX 1+2/TRIO.BAS MULTISTATION with 1-3 Satellites - large 56x43x31h cm - medium 56x43x21h cm
394 ROBUSTUS MEDIUM carrying case for TRIO.BAS MULTIFLEX 1+2/RABS ISOLATOR with 1-3 Satellites - 56x43x31h cm
395 ROBUSTUS STANDARD carrying case - 48x38x17h cm
398 ROBUSTUS LARGE carrying case TRIO.GAS - 56x43x31h cm
401 ROBUSTUS MEDIUM carrying case for ARBIO - 56x43x22h cm
403 LIGHT carrying case for VERITEST - 34x30x16h cm
524 LIGHT STANDARD carrying case for TRIO.BAS MINI - 43x35x19h cm
Ultra-light and compact portable Bluetooth printer with high printing autonomy. It has an end paper sensor and prints most popular barcodes. A practical belt hook, a battery charger, one paper roll and USB cable are included.
Size 11x9x5h cm - weight 450 gr.
421 - ROLL REFILLS
For BLUETOOTH PRINTER - size 57 mm - 10 x box
For BLUETOOTH PRINTER - size 57 mm - 10 x box FEATURES - no erasable thermal paper for TRIO. PRINTER - The paper is printed thermally but it keeps the ink during the time




This miniature barcode reader, frequently used in microbiological air monitoring procedures, can help save time, better control the activity of the operators and achieve complete traceability of the sampler tests - size 6x3,5x1,5h cm - weight 45 gr.

301 - PCU PORTABLE COMMAND UNIT. It has a 7” LCD display. The Bluetooth connection with all TRIO.BAS instruments allows download of sampling data. The PCU can also be used to remotely switch on, switch off and pause the air sampler. The data downloaded from the instruments through the PCU can be transferred to a PC where software is installed (i.e. by USB connection). The Portable Command Unit is an ideal instrument to simplify and to facilitate the activity of operator.
295

“AS” Software, which stands for Air Sampler Software, is a software that allows the transfer of sampling data from the air sampler to the PC for recording or further analysis.
The data transfer is possible via Bluetooth for all air samplers or via USB cable for cable models only.
295 “AS” Software - transfer data from instrument to PC via Bluetooth or via cable (for cable models only)
300
296

APP Android “ASAPP” - transfer data from instrument to Android smartphone / table
“BAS” Software is a software which is complaint with CFR 21 Data Integrity as data attends the data standards of ALCOA:
- A ttributable as all individuals need to log in with a password
- L egible as data is easy to understand and to be recorded permanently
- C ontemporaneous as data is recorded when observed
- O riginal as data is accessible in the original form
- A ccurate as free of errors and complaint with the protocol
The data transfer from air sampler to PC is possible via Bluetooth for all air samplers or via USB cable for cable models only.
BAS SW simplifies the entry of user profiles and sampling programs.
296
302

“BAS” Software - transfer data from instrument to PC via Bluetooth or via cable (for cable models only)
APP Android “BASAPP” - transfer data from instrument to Android smartphone / table
For industries involved in pharmaceutical and healthcare products or laboratories, equipment quality is very important and even small inconsistencies can generate disastrous results. Installation Qualification (IQ), Operational Qualification (OQ) and Performance Qualification (PQ) are essential components of quality assurance. IQ OQ PQ protocols establish that the equipment, which is installed and used, offers a high quality assurance, so that manufacturing processes will consistently produce products that meet predetermined quality requirements.
ORUM INTERNATIONAL offers an accurate service of maintenance and calibration of the whole range of TRIO.BAS samplers, directly or through the qualified technical assistance centers of its distributors.
In particular, the periodic calibration of the instruments is carried out using best practice metrology methods by highly qualified technicians.
ORUM INTERNATIONAL, as the inventor of portable microbiological samplers with more than 40 years of experience, is able to provide technical support to your staff (QC) to facilitate the implementation of the entire range of TRIO.BAS samplers in your daily testing routine.

We recommend official calibration of the air samplers every 6-12 months. We also recommend a recalibration when the air sampler is potentially damaged, the flow rate is compromised, or any time the firmware is upgraded.
During the recalibration, the air sampler’s flow rate is checked to guarantee the value of aspirated air is consistent and the instrument works correctly. A detailed certificate of calibration is subsequently issued after the calibration.





